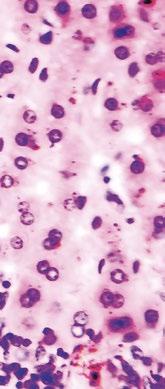

Rota+Coli+Clos

![]()

Rota+Coli+Clos

5 DOSIS
25 DOSIS
TRIPLE PROTECCIÓN EN CADA DOSIS
EXCELENTE PERFIL DE SEGURIDAD

En el panorama actual de la producción porcina, la búsqueda de la excelencia ya no puede limitarse a gestionar crisis puntuales: anticipar, sistematizar y profesionalizar son imperativos en un contexto donde los retos superan lo técnico y abarcan lo humano, sanitario y ambiental.
El sector se enfrenta a un futuro incierto, aunque lleno de oportunidades si logramos sostener una visión integral.
La provisión de proteína animal sigue siendo esencial, pero la presión normativa en bienestar animal y medio ambiente ha dejado claro que solo quienes prioricen una bioseguridad completa, desde las barreras visibles hasta los reservorios ocultos, podrán avanzar.
La excelencia empieza antes de introducir la primera cerda en la granja y termina después de enviar el último cerdo al matadero: requiere un decálogo de buenas prácticas, gestión de nulíparas, nutrición adaptada, control productivo entre otros y, sobre todo, anticipación y análisis.
Es fundamental regresar cada vez al terreno de la formación y el compromiso humano, donde verdaderamente se marca la diferencia.
La ciencia también nos impulsa a renovar el enfoque.
Si años atrás, evitar el sufrimiento bastaba para hablar de bienestar animal, hoy la medición y estudio del estado emocional positivo de los cerdos es la nueva frontera: el juego, la exploración y el movimiento de la cola son ya indicadores esenciales.
Trabajos recientes de centros como IRTA y de proyectos europeos establecen rutas a seguir: indicadores conductuales fiables y herramientas prácticas para integrar el bienestar emocional a la rutina productiva. Es ética, sí, pero también es una ventaja competitiva y reputacional.
La bioseguridad ha de entenderse como un principio irrenunciable, un doble escudo, externo e interno, que debe proteger día a día el esfuerzo de meses.
Menos atención reciben los puntos ciegos: esos focos ocultos de contaminación que solo una gestión exhaustiva y la formación continua pueden controlar. El enfoque “360°” es literal: la rentabilidad y la salud animal dependen de no dejar grietas en el sistema.
El compromiso del sector frente a la resistencia a los antibióticos se refuerza con la ejecución del PRAN 2025-2027.
La experiencia española ha demostrado que la colaboración de empresas, administración y profesionales reduce el consumo de antibióticos sin perder eficiencia, siempre alineados con el modelo One Health. Los programas PROA, el refuerzo de la vigilancia y la formación continua deben consolidar lo logrado y abrir nuevas perspectivas para frenar resistencias microbianas, un desafío que también es de salud pública y sostenibilidad.
El control ambiental en las granjas no puede pasar a un segundo plano.
Garantizar la ventilación adecuada es esencial para la salud, el bienestar y la productividad. Sistematizar el manejo de herramientas de medición, mantener parámetros ambientales óptimos y trabajar en la prevención evitará pérdidas invisibles y reforzará la sustentabilidad de las explotaciones.
Solo la combinación de tecnología, competencia técnica y vigilancia constante traerá los mejores resultados.
No se puede soslayar la “otra gran crisis”: la de las personas. Atraer y retener talento implica empleo estable, comunicar bien las ventajas de trabajar en la producción animal y más concretamente en las granjas y crear un buen ambiente laboral.
No basta con lamentarse por la competencia de otros sectores, hay que convertir el nuestro en un lugar atractivo, invirtiendo en formación y adaptándonos a las expectativas de las nuevas generaciones. ¡Sin personas motivadas y formadas, ni la mejor tecnología ni la ciencia bastan!
Nos esperan meses de retos y de transición, pero también de oportunidades para liderar desde la profesionalidad, la innovación y, sobre todo, desde el cuidado de las personas y los animales. Porque alcanzar la excelencia no es un destino, sino una actitud que nos obliga a mejorar juntos cada día.
PUBLICIDAD
Laura Muñoz
+34 629 42 25 52
Luis Carrasco
+34 605 09 05 13
REDACCIÓN
Daniela Morales
Laura Pérez
Óscar Cáceres
COLABORADORES
Alberto Morillo Alujas
Jordi Baliellas
Vicens Enrique-Tarancón
Fernando Laguna
ADMINISTRACIÓN
Mercè Soler
Barcelona
España
Tel: +34 93 115 44 15
info@agrinews.es www.porcinews.com
Precio de suscripción anual: España 30€
Extranjero 90€
DIRIGIDA A VETERINARIOS DE PORCINO
Depósito Legal Porcinews B17989-2015
ISSN (Revista impresa) 2696-8029
ISSN (Revista digital) 2696-8037
Revista Trimestral
La dirección de la revista no se hace responsable de las opiniones de los autores. Todos los derechos reservados.

4/18
Decálogo para alcanzar la excelencia en granjas de producción porcina







Andrea Martínez Martínez1, Anabel Fernández Bravo1, Emilio José Ruiz Fernández1, Simón García Legaz1, Manuel Toledo Castillo2, Elena Goyena
Salgado3 y José Manuel Pinto Carrasco4
1Veterinaria/o de Producción, Agropecuaria Casas Nuevas
2Veterinario jefe de Producción, Agropecuaria Casas Nuevas
3Profesora de la Universidad de Murcia
4Ingeniero Agrónomo, SAT Hnos. Chico
Claves prácticas para mejorar la eficiencia, el bienestar y la sostenibilidad en producción porcina.
20/26
Digitalización, predicción y compromiso con la sociedad en la producción porcina
Cristina Sanmartín, José Ángel Fernández, Monse Suárez y Gonzalo Cano OPP Group
28/32
El papel del enriquecimiento ambiental en la mejora del bienestar y rendimiento zootécnico en porcino
Servicio Técnico de AMBiotec
34/40
Desarrollo de indicadores fisiológicos y conductuales de estado emocional positivo en cerdos



Emma Fàbrega Romans1, Liza y Marc Bagaria1
Programa de Bienestar Animal del IRTA,
Research Institute for Farm Animal Biology (FBN), Dummerstorf
El desarrollo de indicadores fisiológicos y conductuales permite avanzar en la evaluación objetiva del estado emocional positivo en cerdos.
42/48
Cerdas hiperprolíficas: ¿pueden coexistir el rendimiento y el bienestar?
Anouk Cottin-Tillon
Jefe de Mercado Monogástricos – Jefo
50/52
Evolución en la alimentación de los destetes: el sistema iQon Multifast™ lo hace posible
New Farms
54/60
Nutrición porcina: aliado clave en la evolución de la industria
Departamento técnico de PRODUMIX
62/73
Bioseguridad porcina 360°: de las barreras visibles a los reservorios ocultos - Parte I

David García Páez
Especialista en Bioseguridad Aplicada en OneSilex
Explora cómo aplicar una bioseguridad porcina efectiva más allá de las medidas visibles, protegiendo la explotación desde el perímetro hasta los focos internos de riesgo.
74/78
Acidificación del agua en transición porcina: salud intestinal y producción
Equipo técnico Bbzix
80/86
Vacunación: herramienta decisiva en la prevención del PRRS y Circovirus Porcino tipo 2
Servicio Técnico de Boehringer Ingelheim
88/92
PRAN 2025-2027: Una estrategia integral para preservar la salud pública, animal y ambiental



María J. Vilar1, Cristiana
eixeira Justo1 y Cristina
Muñoz Madero2
1Técnico científico del PRAN en Sanidad Animal
2Coordinadora del PRAN en Sanidad Animal
El PRAN 2025-2027 representa un avance decisivo en la mejora de la sanidad animal, promoviendo un uso responsable y sostenible de los antimicrobianos.
94/98
Proteger frente al virus PRRSCepa Rosalia
Javier Abadías, Clara Farré, Jonás Hernández y Ester Maiques
Servicio Técnico Porcino ZOETIS
100/106
Ventilación en granjas porcinas: clave para el bienestar y la productividad

Laura Batista
Asesora para el sector porcino mundial
Una ventilación adecuada en granjas porcinas es esencial para garantizar el bienestar animal, la salud de los trabajadores y la sostenibilidad productiva.
108/112
Influencia del método de aplicación de productos de hierro y anticoccidios en el comportamiento de lechones lactantes y en los factores asociados a estrés
María Rodríguez1, Joaquín Morales1, Gonzalo Díaz-Amor1, Antonio González-Bulnes2, Hamadi Karembe3 y Daniel Šperling3
1PigCHAMP Pro Europa S.L.
2Universidad Cardenal Herrera-CEU
3Ceva Santé Animale
114/115
Foro Porcino Aragón INTERPORC
Equipo Técnico Interporc
116/120

Es momento de atraer y retener talento
Laura Pérez Sala
Veterinaria especialista en producción porcina & Personal Coach
Atraer y retener talento exige repensar el entorno laboral porcino para hacerlo más motivador, formativo y generacionalmente
Agradecemos a nuestros anunciantes por hacer posible la publicación de esta revista: AMBiotec, Arvet Veterinaria, Biocidas Zix, Bioplagen, Boehringer Ingelheim Animal Health, Ceva Salud Animal, Datamars Livestock, ENESA, Innofarm, Interporc, Intracare, Jefo, Lidervet, Liptosa, Nediver-Axiom, New Farms, OPP Group, Produmix/Igusol, Quimicamp Higiene, Quimunsa, Vetia Animal Health y Zoetis.
Andrea Martínez Martínez1, Anabel Fernández Bravo1, Emilio José Ruiz Fernández1, Simón García Legaz1, Manuel Toledo Castillo2, Elena Goyena Salgado3 y José Manuel Pinto Carrasco4
1Veterinaria/o de Producción, Agropecuaria Casas Nuevas
2Veterinario jefe de Producción, Agropecuaria Casas Nuevas
3Profesora de la Universidad de Murcia
4Ingeniero Agrónomo, SAT Hnos. Chico
En este artículo se describen, de forma práctica, las áreas y acciones necesarias para lograr la máxima producción en una granja porcina, abordando los puntos clave que más influyen en la productividad de este tipo de explotaciones.


Existen varios aspectos críticos en el manejo de las nulíparas en la granja. A continuación, desarrollaremos los cuatro más importantes: el número de nulíparas que ingresan, su adaptación sanitaria, la salud intestinal y la adaptación productiva.
Número de nulíparas que ingresan en la granja
El número de nulíparas que ingresan en la granja condiciona directamente el número de cubriciones por banda, ya que la reposición debe ajustarse a la dinámica productiva de la granja.
Una estructura censal con un porcentaje excesivo de cerdas de primer parto puede dar lugar a camadas con un estatus inmunitario deficiente.
Un censo con demasiadas cerdas multíparas (especialmente a partir del séptimo ciclo) implica mayores costes de alimentación, un aumento en el número de nacidos muertos y una mayor variabilidad en el peso de los lechones al destete.
El equilibrio ideal se sitúa en torno al 20 % de cerdas de primer parto, un 70 % entre los ciclos 2 y 6, y un 10 % con 7 ciclos o más (Gráfica 1), en consonancia con una adecuada presión de desvieje.
25 20 15 10 05
Gráfica 1. Comparación entre una estructura censal correcta (línea verde) e incorrecta (línea rosa)en una granja porcina, según el porcentaje de cerdas por ciclo reproductivo.
La cubrición de las nulíparas debería realizarse cuando pesen más de 145 kg por dos razones fundamentales.
Se estima que el crecimiento durante la gestación ronda los 40 kg, lo que permite alcanzar los 195 kg al parto, favoreciendo así una mayor ingesta de pienso en esta fase.

Cubrir a las cerdas cuando han alcanzado el tercer celo se asocia con un mayor nivel de ovulación y una mayor longitud uterina, factores que contribuyen a mejorar la prolificidad en el primer parto.

La adaptación sanitaria y el manejo de los flujos de las nulíparas, hay que entenderlas desde dos puntos de vista:
La capacidad de las nulíparas de alterar la sanidad de las multíparas.
La capacidad de las multíparas de infectar a las nulíparas.
Por tanto, es necesario elaborar un programa sanitario a la medida de la granja de destino y luego se deben manejar los flujos de las primerizas.
Lo ideal es mantener a las primerizas separadas de las multíparas hasta el momento del parto, ya que esto permite un mayor tiempo de adaptación y evita la mezcla de lotes de nulíparas.
Es fundamental diseñar un programa sanitario específico que minimice los desafíos sanitarios en esta fase y garantice el desarrollo de una inmunidad sólida frente a las enfermedades endémicas presentes en la granja.
La salud digestiva de las nulíparas influye directamente en su respuesta a las vacunas, ya que está estrechamente relacionada con la inmunidad.
Un mal estado intestinal puede dar lugar a fallos vacunales en los que las nulíparas desempeñan un papel relevante, aumentando la incidencia de diarreas neonatales en los lechones.
Mantener una buena salud intestinal en las nulíparas es clave para mantener un estatus inmunitario elevado en la granja.

El uso de ácidos grasos de cadena media y otras moléculas, como los antioxidantes, contribuye a mejorar la salud intestinal y, en consecuencia, la salud general del animal. Además, ayudan a prevenir disbiosis asociadas al proceso de adaptación de las nulíparas al microbiota de la granja de destino.
Adaptación productiva
La adaptación y aclimatación a las instalaciones son claves para la tasa de retención de las cerdas, definida como el porcentaje de nulíparas que ingresan en la granja y no son eliminadas antes del tercer parto.
La aclimatación al box y la eliminación de cualquier manejo estresante en los 20 días previos a la cubrición son fundamentales para evitar una disminución en el consumo de pienso, lo que podría provocar una reducción en la ovulación.
Media de nacidos muertos por camada
Consumo de pienso en gestación
GESTACIÓN TEMPRANA
Durante el primer tercio de la gestación es necesario estimular un alto consumo de pienso.



Gráfica 2. Evolución de la media de lechones nacidos muertos por camada según el número de partos.
En esta fase se produce un aclaramiento de la progesterona sistémica, pero existe también una producción local de progesterona, así como la acción de otras hormonas que influyen en el desarrollo y la calidad placentaria.
Por ello, a partir del tercer día tras la cubrición, debe incrementarse la cantidad de pienso suministrado.






Propiedades desinfectantes aún más poderosas
El único biocida con registro
El
EU-BPR en clasifi cación
PT02, PT03, PT04 y PT05
Más sostenible y preparado para los retos del futuro


























Pioneros en soluciones preparadas para el futuro















Secuestrante de micotoxinas
con ingredientes cuidadosamente seleccionados:

Silicatos y aluminosilicatos
Paredes celulares y productos de fermentación microbiana
Provitaminas
FOS + MOS
Componentes vegetales
Harina de algas




Una de las teorías que justifican el aumento del pienso en esta etapa es la búsqueda de un mayor peso al nacimiento de los lechones (Gráfica 3).
Sin embargo, se ha demostrado que este efecto no se produce e, incluso, puede llegar a ocasionar fallos vacunales.
Además, se ha demostrado que el aumento del consumo de pienso al final de la gestación influye negativamente en la producción de calostro (Gráfica 4).

Gráfica 3. Relación entre el consumo de pienso en el último tercio de gestación y el peso medio al nacimiento (LN) de la camada, en nulíparas y multíparas. No se observan diferencias significativas en el peso de los lechones al nacimiento al aumentar la ración diaria de 1,8 a 2,2 kg.
Producción de calostro (kg)
Consumo pienso (kg/día)
Gráfica 4. Relación entre el consumo de pienso en el último tercio de gestación y la cantidad de calostro producido. A medida que aumenta la ración diaria (de 1,8 a 3,3 kg/día), la producción de calostro disminuye progresivamente.

En definitiva, aumentar el aporte de pienso al final de la gestación no incrementa el peso del lechón al destete, disminuye la producción de calostro y provoca que las cerdas lleguen al parto con un exceso de condición corporal, lo que conlleva consecuencias negativas durante el parto y el inicio de la lactación.
Las cerdas deben comenzar a comer desde el primer día postparto y, para que esto ocurra, es fundamental haber manejado correctamente la alimentación durante la gestación.
Como concepto general en lactación, el objetivo es alcanzar los consumos más altos posibles. Para ello, deben tenerse claras tres ideas fundamentales:
El consumo elevado de pienso permite un aumento significativo en la producción de leche, lo que se traduce en un mayor peso de los lechones al destete.

Este parámetro es un buen predictor de su eficiencia en fases posteriores.
Evitar la pérdida de peso de la cerda durante la lactación favorece una mejor tasa de ovulación en el siguiente celo, lo que se traduce en una mayor prolificidad.
Existe una tendencia actual que sugiere que las vacunaciones en maternidad pueden provocar una disminución del consumo de pienso durante la lactación, lo que afectaría negativamente a la productividad.
Sin embargo, nuestra experiencia — apoyada por el uso de nuevos dosificadores electrónicos— ha demostrado que esto no se produce: no se observan pérdidas de consumo, ni alteraciones en la fertilidad o prolificidad del siguiente ciclo.
En el caso de las cerdas de primer parto, se ha comprobado que la vacunación realizada entre los días 9 y 11 de lactación no genera ningún tipo de contingencia en la curva de consumo (Gráfica 5).
Consumo de pienso (kg/día) Días de lactación
Gráfica 5. Curva de alimentación en maternidad. Se observa un aumento progresivo del consumo de pienso durante los primeros días de lactación, estabilizándose entre los días 13 y 26 en torno a los 5 kg/día. La vacunación realizada entre los días 9 y 11 no interfiere con la curva de consumo, lo que confirma la ausencia de contingencias asociadas.

Uno de los factores determinantes para una producción porcina de calidad es la edad al destete, ya que esta influye directamente en:
El grado de madurez de los lechones.
La capacidad para alcanzar buenos resultados productivos en las fases posteriores de transición y engorde.

Un aspecto clave es la permeabilidad intestinal.
Si no se alcanza un grado suficiente de madurez, la integridad intestinal es limitada, lo que permite el paso de alérgenos y patógenos desde el intestino al sistema circulatorio, comprometiendo la salud de los lechones en las primeras fases de la transición.
El control del PRRS en lechones nacidos muertos tiene una gran importancia para verificar la ausencia de recirculación del virus durante la gestación.

Paralelamente, la detección del virus al final de la gestación, mediante extracción de sangre, permite valorar la posibilidad de infección en la fase de lactación.
Conocer el momento exacto en que se produce la recirculación viral facilita la implementación de medidas de manejo adecuadas, especialmente en lo que respecta a la organización de los flujos de las cerdas gestantes.
Una herramienta adicional es la separación de las lenguas de los lechones nacidos muertos según el origen —nulíparas o multíparas—, lo que permite identificar en qué grupo se concentran los mayores problemas y, en consecuencia, aplicar medidas correctoras.
La infección puede producirse en ambas direcciones: las nulíparas virémicas pueden transmitir el virus a las multíparas, y estas, a su vez, pueden infectar a las nulíparas, que presentan una menor inmunidad.
Tras el destete, las cerdas deben recibir la mayor cantidad de pienso posible.
El uso de camisas de gestación es una herramienta útil en este sentido, ya que limita las agresiones entre animales y permite alcanzar altos niveles de consumo desde el primer día.
A partir del tercer día posdestete, debido al estímulo estrogénico, las cerdas tienden a reducir ligeramente la ingesta, por lo que es aconsejable ajustar la cantidad de pienso en consecuencia.
El objetivo es que al menos el 95 % de las cerdas destetadas entren en celo antes del sexto día. Si este parámetro no se cumple, es probable que exista un problema relacionado con la alimentación en lactación o durante el intervalo destete-celo.
Las dosis deben administrarse cada 24 horas mientras la cerda permanezca en celo.
No se deben cubrir cerdas al final del celo, cuando el reflejo de inmovilidad no es claro, ya que esto puede provocar descargas debido a que la cubrición se realiza en una fase con predominio de la progesterona.
Es importante contar con un sistema sencillo para el manejo de las cerdas que no manifiestan celo.
Una estrategia habitual y efectiva consiste en moverlas de ubicación para generar un pequeño estrés que estimule la aparición del celo en la semana siguiente.
En caso de que el celo se haya producido durante la maternidad, debe esperarse el tiempo necesario hasta que la cerda vuelva a mostrarlo. 95%

Las cerdas con un intervalo destete-celo más corto tienden a presentar un celo de mayor duración.
En estos casos, puede ser necesario aplicar una dosis adicional de inseminación.
Se recomienda realizar la detección de celo una vez al día, lo que facilita la planificación de los turnos de trabajo en la granja.

En lo que respecta al manejo de los flujos de animales, es fundamental establecer un protocolo claro para la ubicación de los animales en gestación. Algunas recomendaciones clave son:
Los distintos lotes de nulíparas que ingresen en la granja deben mantenerse separados entre sí.
Esta separación dependerá del espacio disponible en las instalaciones, pero resulta clave para controlar posibles diferencias sanitarias o de adaptación.
SEPARACIÓN ENTRE NULÍPARAS Y MULTÍPARAS
Siempre que sea posible, las nulíparas deberían mantenerse separadas de las multíparas hasta el momento del parto.
La dinámica jerárquica en los grupos de cerdas puede generar situaciones de agresión, en las que las nulíparas tienden a ser las más perjudicadas.
Minimizar el estrés durante la gestación —ya sea derivado del manejo, la alimentación, las condiciones de las instalaciones o la presencia de enfermedades— es esencial para garantizar la calidad de los lechones.
En situaciones de estrés, se altera la actividad de la enzima 11β-hidroxiesteroide deshidrogenasa tipo 2, responsable de transformar el cortisol activo en cortisona inactiva.
Si esta enzima pierde funcionalidad, se incrementa la exposición fetal al cortisol, lo que puede afectar negativamente al desarrollo de los lechones.
La fase de periparto gestación a la lactación.
Durante este periodo se producen cambios hormonales y metabólicos relevantes, que tienen un impacto directo en la mortalidad de los lechones y en su desarrollo posterior.
Por ello, a continuación, se presentan una serie de pautas básicas de manejo tenerse en cuenta para optimizar esta fase crítica:

Una correcta administración del pienso en el periodo periparto está directamente relacionada con la cantidad de lechones nacidos muertos.
Cuanto mayor sea el intervalo entre la última comida y el inicio del parto, mayor será el número de nacidos muertos.
El aporte de fibra en la ración ayuda a reducir el estreñimiento, lo que tiene efectos positivos en dos aspectos:
Disminuye el intervalo entre el nacimiento de cada lechón, reduciendo así el riesgo de nacidos muertos.
Limita el paso de toxinas desde el útero hacia la glándula mamaria, cuyo epitelio, en esta fase, es altamente permeable debido a la formación de calostro (recordemos que el calostro es un trasudado del suero).
Es fundamental que las cerdas ingresen limpias a las salas de maternidad.
Un paso previo por una ducha de agua ayuda a reducir la carga microbiana y mejora la bioseguridad de la sala.
Es imprescindible verificar que las cerdas presentan buenos aplomos, un estado sanitario adecuado y una condición corporal óptima, lo que permite anticipar posibles contingencias y aplicar medidas de control individualizadas si fuera necesario.
Se debe establecer un protocolo de monitorización específico para las cerdas primerizas y las cerdas de mayor edad, ya que son los grupos en los que se concentra la mayor parte de los problemas durante el parto y se registra un mayor número de lechones nacidos muertos.

Maximizar el consumo de pienso durante la lactación es uno de los aspectos clave para alcanzar altos niveles de productividad, ya que la edad y el peso de los lechones al destete son factores predictivos fundamentales de su rendimiento y eficiencia en fases posteriores.
Para ello, es importante establecer curvas de alimentación que optimicen el consumo de pienso.

El nivel de consumo alcanzado en lactación estará directamente condicionado por el manejo aplicado durante esta fase.
Destetar a los 28 días permite aprovechar una mayor madurez digestiva de los lechones, aspecto especialmente relevante en contextos de producción sin óxido de zinc y sin el uso de antibióticos.
Además, cualquier intervención orientada a reducir la pérdida de condición corporal en la cerda tendrá un efecto positivo sobre la tasa de ovulación y los resultados de supervivencia embrionaria en el siguiente ciclo reproductivo.

El establecimiento de programas vacunales debe contemplarse desde diferentes enfoques complementarios:
Vacunación de reproductoras para transferencia de inmunidad vía calostro
La vacunación de las cerdas gestantes tiene como objetivo proporcionar a los lechones una adecuada protección pasiva a través del calostro, enfoque que cobra especial relevancia frente a patógenos implicados en diarreas perinatales.
El programa vacunal suele aplicarse entre los días 80 y 100 de gestación con el fin de alcanzar niveles elevados de anticuerpos en el momento del parto, que es cuando se produce el calostro.
Para el resto de enfermedades presentes en la granja, la vacunación en sabana (vacunación masiva de todos los animales) es una herramienta eficaz.
Esta estrategia contribuye a reducir la transmisión horizontal de patógenos y mejora el estatus sanitario global.
El uso combinado de vacunas comerciales y autovacunas permite reforzar la inmunidad colectiva y disminuir la presión de infección.
Es imprescindible implementar un protocolo vacunal específico para las nulíparas durante su periodo de adaptación.
Este programa debe ajustarse a la situación sanitaria particular de cada granja con el objetivo de proteger a las nulíparas frente a las principales patologías endémicas y garantizar su integración en la dinámica productiva sin comprometer la bioseguridad del sistema.
Los protocolos de limpieza y desinfección son imprescindibles, ya que constituyen la principal herramienta para reducir la presión de infección en las granjas.
El equilibrio entre la inmunidad de los animales y la presión de infección del entorno es lo que, en última instancia, define el estado sanitario de la explotación.
Asimismo, es fundamental verificar periódicamente la calidad del agua, tanto desde el punto de vista bacteriológico como fisicoquímico.
Para ello, deben establecerse controles regulares que aseguren que el agua suministrada cumple con los requisitos necesarios para no comprometer la salud de los animales ni la eficacia de los tratamientos orales.
Otro punto crítico es el control de roedores, ya que, además de ser transmisores de enfermedades, generan importantes daños en las instalaciones y alteran el mantenimiento general de la granja.


PRODUCTIVOS COMO HERRAMIENTA
El análisis de datos es una herramienta fundamental para comprender qué está ocurriendo en la granja, tomar decisiones y, sobre todo, evaluar el impacto de esas decisiones.
Es indispensable que los datos recogidos sean veraces y consistentes: es preferible contar con pocos datos fiables que con muchos datos de escasa calidad.


Los principales parámetros de producción que deberían monitorizarse en una granja porcina incluyen:
Este parámetro permite evaluar la calidad de la recela y el manejo de la alimentación durante la lactación.
Valores superiores a 5 días en destetes a 28 días indican una situación no deseable y posibles deficiencias en el manejo.
>5 días
Incluye tanto las cerdas que entran en celo tras el destete como aquellas que repiten celo.
Es un indicador clave de eficiencia reproductiva, ya que refleja la capacidad de la granja para lograr cubriciones exitosas en el menor tiempo posible.

La fertilidad al ecógrafo evalúa la eficiencia del manejo en la recela y la cubrición.
La tasa de partos, definida como el porcentaje de cerdas cubiertas que finalmente paren, es uno de los principales indicadores de éxito reproductivo, ya que revela las pérdidas productivas en el ciclo.

Estos valores ofrecen una visión clara de la productividad real de la granja y permiten identificar áreas de mejora, especialmente para reducir la mortalidad perinatal.
Es un indicador relevante tanto de la patología en los lechones como en las cerdas.
Un porcentaje elevado de bajas puede señalar problemas sanitarios o de manejo y permite evaluar la eficacia de las medidas implementadas.
Además del número, es importante registrar información adicional, como el momento en el que se produce la baja y si la cerda fue tratada o no.
Esto permite analizar las causas y ajustar los protocolos de manejo o intervención veterinaria.
Alcanzar la excelencia en producción porcina requiere integrar sanidad, nutrición, manejo y análisis de datos de forma coordinada. La clave está en la prevención, la anticipación y la toma de decisiones basadas en evidencias.
Solo así se optimiza el rendimiento sin comprometer el bienestar animal.
Decálogo para alcanzar la excelencia en granjas de producción porcina DESCÁRGALO EN PDF


Reconocidas mundialmente por su precisión y durabilidad, las básculas y lectores de Tru-Test se integran perfectamente con la identificación electrónica de los animales y proporcionan el máximo control sobre la rentabilidad del ganado al aumentar la precisión y eficiencia de la recogida de datos.
Los administradores de fármacos SIMCRO y NJPHILLIPS de DATAMARS, son famosos por su exactitud y comodidad, garantizando dosis completa y correcta en todo momento.
Las innovadoras soluciones DATAMARS para porcino ofrecen funciones de seguridad integradas que protegen tanto animales como operarios.







Cristina Sanmartín, José Ángel Fernández, Monse Suárez y Gonzalo Cano OPP Group

Anticipar eventos futuros y contar con información precisa en tiempo real es relevante para los procesos de producción.
La incorporación de modelos de inteligencia artificial permite optimizar los procesos, así como mejorar el control y la toma de decisiones.
Las granjas porcinas requieren, de manera imprescindible, sistemas que faciliten la predicción y el control de sus procesos productivos.
En este ámbito, se distinguen dos dimensiones interdependientes:
El componente mecánico, fundamental para garantizar el bienestar animal.
Los propios animales.
La tecnificación se ha consolidado en las explotaciones porcinas, integrando diversas aplicaciones y sensores destinados a la recopilación de datos que facilitan tanto el funcionamiento eficiente de los equipos instalados como la elaboración de informes para el seguimiento y análisis de la productividad.
Esta información respalda la toma de decisiones en la gestión y manejo de las explotaciones.
SMART FARMS MOTHER – LA REVOLUCIÓN TECNOLÓGICA DEL SECTOR PORCINO
En un contexto donde la eficiencia, trazabilidad y sostenibilidad se han vuelto pilares fundamentales de la industria agroalimentaria, Smart Farms Mother emerge como una solución tecnológica integral que revoluciona la gestión de la cadena de producción porcina.

El principal valor de Smart Farms
Mother reside en su capacidad para monitorizar en tiempo real los KPI’s (Indicadores Clave de Desempeño) de cada fase del proceso productivo.

A través de una visualización clara y dinámica, los responsables de producción pueden identificar cuellos de botella, pérdidas de eficiencia o desviaciones en parámetros críticos —como tasas de fertilidad, crecimiento, conversión alimenticia o calidad del producto final—, permitiendo una toma de decisiones rápida y basada en datos precisos.
Uno de los desafíos históricos de la producción porcina ha sido la desconexión entre departamentos técnicos y estratégicos, tanto en grandes compañías verticalizadas como en granjas particulares.
No es nada fácil, cada responsable de área tiene su criterio y su ‘’modus operandi’’.
Por tanto Smart Farms Mother propone una solución que rompe esos silos, permitiendo una conexión transversal entre áreas clave como:
Genética y selección

Bioseguridad y prevención de riesgos
Nutrición y formulación de piensos
Sanidad y control de enfermedades
Instalaciones y mantenimiento
Tecnología e IoT aplicada en granjas
Software de gestión y trazabilidad
Departamentos financieros y contables
Recursos Humanos y gestión de personal
Sostenibilidad y medio ambiente
Este enfoque permite tratar cada granja o empresa como parte de un ecosistema funcional donde todas las áreas interactúan y donde el fallo de una puede repercutir directa o indirectamente sobre las demás. Por ejemplo:

Si salta una alarma en los KPI del área sanitaria por un brote infeccioso, Smart Farms Mother puede detectar automáticamente cómo podría impactar en la densidad animal (genética y producción), en la necesidad de recursos adicionales (finanzas y RRHH), en los flujos de alimentación (nutrición) o en los requisitos de bioseguridad y sostenibilidad.
Un fallo genético en el inicio de la pirámide de producción puede arrastrar defectos a las siguientes líneas, afectando directamente la calidad reproductora y la viabilidad de esos individuos. Esto impacta negativamente en los resultados productivos, generando una necesidad de alta reposición, menor cantidad de lechones viables capaces de llegar a matadero y, en consecuencia, la obligación de adquirir animales externos a la empresa para mantener la carga óptima del matadero.

La plataforma no solo ofrece una visualización en tiempo real de estos efectos en cadena, sino que también propone análisis predictivos y distintas soluciones posibles, ayudando a los responsables a decidir de forma rápida y eficaz.
Gracias a esta capacidad integradora, Smart Farms Mother es adaptable tanto para grandes grupos verticalizados como para pequeños productores, sirviendo como una herramienta común que permite a todo el sector trabajar de forma cohesionada, eficiente y estratégica.

Smart Farms Mother facilita la trazabilidad total del producto a tiempo real, desde el origen genético hasta el punto de venta, lo que no solo optimiza los procesos internos, sino que también añade valor ante un consumidor cada vez más exigente con la calidad y la transparencia alimentaria.

El grado de tecnificación de cada explotación determinará su capacidad para recibir y gestionar información precisa y en tiempo real, lo que facilita el monitoreo eficiente de los sistemas de alimentación, distribución de agua, control ambiental, sistema de filtraje de aire y otros procesos asociados.

La calidad de los datos recopilados estará determinada por su veracidad y fiabilidad.
A mayor grado de automatización en el sistema de captura, menor será la incidencia de errores y, consecuentemente, se incrementará la calidad de la información obtenida. Es fundamental coordinar y correlacionar adecuadamente la información recolectada para asegurar el funcionamiento sincronizado de todos los equipos instalados.
La supervisión de los protocolos de manejo de los animales, así como de las acciones asociadas, es fundamental para optimizar la gestión del cuidado de los mismos.
La incorporación de estas tecnologías en las explotaciones implica la instalación de componentes mecánicos y electrónicos que requieren funcionar de manera coordinada y sincronizada.
Una vez que se han instalado los sensores pertinentes en todas las áreas de la granja, es necesario proceder a la recolección de datos.
Este proceso puede llevarse a cabo de manera automática, semiautomática o manual.

La trazabilidad y la transparencia en los procesos productivos se han convertido en requisitos esenciales para la sociedad actual.
El sector porcino debe considerar este contexto como una oportunidad y, a través de la implementación de las tecnologías previamente mencionadas, abrir sus instalaciones para mostrar de manera objetiva las condiciones de producción.


Imagen 2. Granja Premier Pig. Formando a futuros veterinarios a través de la UDL.
Conforme se va legislando se requiere un mayor conocimiento para crear nuevos modelos de producción donde la epigenética junto con las nuevas tecnologías permitan introducir esos conocimientos en todas sus fases y lograr una proteína más saludable, de calidad y comprometida con la sociedad para garantizar su consumo en las dietas equilibradas.

Al mismo tiempo, es fundamental abrir las puertas del sector a los futuros talentos: desde trabajadores a pie de campo hasta responsables de áreas, veterinarios, técnicos o perfiles especializados en nutrición, sanidad, genética, tecnología o medio ambiente.
Facilitar el acceso a una formación práctica y real en granja permitirá que estos perfiles conozcan de primera mano el potencial de desarrollo profesional que ofrece el porcino.
Esta visión no solo favorece la profesionalización del sector, sino que también contribuye a atraer talento joven al medio rural, fomentando la repoblación de la llamada España vacía y garantizando que el campo siga desempeñando su papel esencial en la alimentación de la población.


Imagen 3. Granja OPPGroup. Formando a futuros veterinarios a través de la UAB.

Imagen 4. Granja Serentill, integrada con Piensos Costa. Visita Máster de Sanidad y Producción Porcina con Opp.

El compromiso con la sostenibilidad ambiental representa un pilar fundamental dentro de la estrategia de transparencia.
La gestión y supervisión tanto de la huella hídrica como de la huella de carbono, junto con la monitorización de las emisiones de gases, proporcionan información detallada—ya sea a nivel individual o colectivo—acerca del uso de insumos y su repercusión en la productividad.
Por ejemplo, la implementación de bebederos electrónicos inteligentes diseñados y desarrollados por OPP Group posibilita el monitoreo preciso del consumo hídrico individual de cada animal.
Estos registros pueden correlacionarse con distintas estrategias nutricionales, facilitando así la adopción de modelos más eficientes en el consumo de agua sin comprometer la productividad, medida en kilogramos de carne transferidos a etapas subsecuentes de la cadena productiva.


El elevado volumen de datos generados debe ser procesado e integrado de forma inmediata en el sistema de gestión responsable de la gobernanza de los equipos tecnológicos instalados en la explotación.
Resulta fundamental contar con una plataforma de integración de datos que posibilite la gestión en tiempo real tanto de los animales como de los sistemas de alimentación, ventilación y otros equipos relacionados.

El concepto de gemelo digital ha posibilitado el desarrollo del proyecto FarmTwin, a través de las dos ayudades Fase 1 y Fase 2 AEI.
Una vez acabado el proyecto hemos centrado el Farm Twin en crear una plataforma de gestión de granja para todo tipo de público participante. Enfocado en la creación de una réplica virtual de la granja, el sistema integra y centraliza la información recogida por los distintos sensores instalados, facilitando así una gestión eficiente y precisa de los datos operativos.




El gemelo digital representa una innovación significativa en la tecnificación de explotaciones porcinas, ya que integra y aprovecha toda la información generada mediante tecnologías como el Internet de las Cosas (IoT) y la inteligencia artificial.
Este sistema consiste en una réplica virtual exacta de la granja física, construida a partir de la recopilación y análisis de datos en tiempo real. Además de reflejar el estado actual de la explotación, el gemelo digital posibilita la simulación de escenarios futuros, facilitando así la predicción del comportamiento productivo y operativo de la explotación.
Una de las principales ventajas del gemelo digital radica en su capacidad para anticipar fallos o requerimientos de mantenimiento en los equipos antes de que se presenten.
Mediante el monitoreo continuo del estado de los componentes mecánicos y electrónicos, se facilita la detección temprana de desgaste y la planificación de intervenciones preventivas, lo que permite minimizar períodos de inactividad y evitar fallos que puedan impactar tanto en la producción como en el bienestar animal.
El gemelo digital, en su función como herramienta predictiva, facilita la realización de simulaciones destinadas a evaluar distintos escenarios y analizar el comportamiento animal, así como el impacto que puede generar la modificación de uno o varios parámetros sobre la salud y productividad.
Por ejemplo, al ajustar variables medioambientales de la granja o componentes de la dieta, el gemelo digital permite anticipar cómo dichas alteraciones influirán en la salud, el crecimiento y el bienestar de los cerdos.

De este modo, se proporciona a los productores una base objetiva para la toma de decisiones informadas, sin requerir intervenciones en el entorno físico real.
Digitalización, predicción y compromiso con la sociedad en la producción porcina
DESCÁRGALO EN PDF


El bienestar animal en el contexto de la producción porcina intensiva ha dejado de ser un concepto exclusivamente ético o regulador para consolidarse como un factor determinante en el rendimiento zootécnico y la sostenibilidad productiva.
Desde una perspectiva fisiológica y etológica, el estrés crónico y las condiciones de alojamiento que limitan la expresión de comportamientos naturales producen alteraciones en el eje hipotálamohipófisis-suprarrenal, con consecuencias inmunosupresoras, digestivas y metabólicas.
Estas disfunciones se traducen en:
Peores índices de Ganancia Media Diaria (GMD).
Mayor heterogeneidad en los lotes.
Aumento de lesiones.
Mayor susceptibilidad a enfermedades.
Un uso más intensivo de antimicrobianos.


El abordaje multifactorial del bienestar requiere intervenciones que incidan directamente sobre la conducta, el entorno y la fisiología del animal.
En este contexto, el enriquecimiento ambiental a través de materiales manipulables o juguetes representa una estrategia eficaz y basada en evidencia para:
Mejorar el confort animal.
Prevenir conductas anómalas como la caudofagia.

Estabilizar la jerarquía social en grupos de animales estabulados.
Diversos trabajos de investigación y experiencias de campo respaldan que la estimulación sensorial y oral adecuada permite reducir la expresión de estrés y mejorar marcadores productivos clave en todas las fases del ciclo de producción.
El marco normativo actual, particularmente el Real Decreto 159/2023 que regula las condiciones de alojamiento y manejo, así como los protocolos de certificación IAWS o WELFAIR®, refuerzan la necesidad de implementar sistemas de enriquecimiento ambiental eficaces, duraderos, seguros y ajustados a la etapa fisiológica del animal.
En este sentido, empresas como Porcsavi, especializada en soluciones para el bienestar y bioseguridad en el sector porcino, ha desarrollado en colaboración con AMBiotec una gama de juguetes enriquecidos diseñados no solo para promover comportamientos naturales, sino para aportar funcionalidad fisiológica.

Mediante la incorporación de ingredientes naturales, extractos vegetales y compuestos bioactivos de alta calidad, estos dispositivos actúan como nutracéuticos ambientales, con efectos beneficiosos sobre la salud digestiva, la microbiota intestinal y la inmunocompetencia del animal.
Etología porcina y necesidades exploratoria
El cerdo doméstico (Sus scrofa domesticus), como especie altamente exploratoria e inteligente, exhibe de forma innata una necesidad de interacción con su entorno mediante conductas como hozar, masticar, olfatear y manipular objetos.
Estas actividades no solo satisfacen necesidades conductuales, sino que promueven la neuroplasticidad, la estabilidad emocional y la cohesión social dentro del grupo.
La ausencia de estímulos adecuados conduce a una desviación conductual caracterizada por estereotipias, agresividad, caudofagia y otros signos de disconfort que impactan negativamente en la productividad.

Para ser considerados efectivos, los materiales de enriquecimiento deben reunir una serie de propiedades recogidas por organismos técnicos como la EFSA, así como por las guías sectoriales españolas. Estos requisitos incluyen:
Manipulabilidad
Capacidad de ser movido, empujado, masticado o deformado por el animal.
Investigabilidad
Estimulación olfativa, gustativa o táctil que mantenga el interés del animal.
Composición segura
Sin riesgo de toxicidad, fragmentación peligrosa ni ingestión obstructiva.

El destete constituye una de las etapas más vulnerables del ciclo por la concurrencia de factores estresantes: separación materna, cambio dietético, reorganización jerárquica y exposición a nuevos patógenos.
El uso de juguetes enriquecidos en esta fase ha demostrado:
Reducción de vocalizaciones y signos de ansiedad.
Aumento del consumo precoz de alimento sólido.
Mejora de la ganancia media diaria en las primeras semanas.
Menor incidencia de diarreas postdestete.
Un avance relevante en este contexto es la incorporación, en los juguetes desarrollados por Porcsavi en colaboración con AMBiotec, de un núcleo fitobiótico.
Los materiales pueden ser de tipo comestible (bloques prensados, cuerdas vegetales), semiduros (maderas blandas) o móviles (pelotas, cadenas), y su combinación optimiza los efectos positivos sobre el comportamiento y el rendimiento.
Innovación y rotación
Diseño que permita la novedad sensorial y evite la habituación.
Durabilidad adecuada
Resistencia mecánica adaptada al nivel de actividad del animal, sin pérdida precoz de estímulo.
Este núcleo está compuesto por aceites esenciales y principios activos de origen vegetal, seleccionados por su efecto antioxidante, antiinflamatorio y digestivo, que contribuyen a mantener una microbiota intestinal equilibrada y una barrera mucosa funcional.
De esta forma, el juguete actúa como un “vector comportamental y nutracéutico”, favoreciendo simultáneamente la conducta natural y la salud gastrointestinal.

Con una presentación adaptada al tamaño del grupo, esta solución representa un apoyo integral frente a los retos del destete, alineada con las estrategias de reducción del uso de antimicrobianos.

Durante el engorde, los grupos presentan un mayor riesgo de aparición de caudofagia, especialmente en ausencia de corte de cola.
La inclusión de enriquecimiento ambiental en esta fase tiene efectos contrastados:
Disminución de la agresividad y las lesiones por mordedura.
Reducción de tratamientos por infecciones secundarias.
Mejora de la homogeneidad del lote.
Incremento de la eficiencia alimentaria.
Los juguetes de Porcsavi para esta etapa están formulados con compuestos naturales que inducen relajación y estimulan la manipulación oral sostenida, manteniendo el interés a lo largo de 6-8 semanas.

El manejo grupal de cerdas gestantes en parques requiere especial atención al bienestar, dado que los episodios de agresión afectan negativamente a la implantación embrionaria y aumentan la variabilidad de camada.
El enriquecimiento ambiental durante la gestación contribuye a:
Reducción de conflictos jerárquicos.
Mejora de la estabilidad emocional.
Disminución de lesiones dérmicas y cojeras.
Mejora de los parámetros reproductivos (partos exitosos, lechones nacidos vivos).

Los productos enriquecidos desarrollados para esta fase integran ingredientes de efecto relajante y atractivos sensoriales que captan la atención de la cerda y permiten desviar la conducta exploratoria lejos de los flancos de sus compañeras.
Además, su diseño evita el deterioro prematuro, permitiendo un uso continuo sin necesidad de reposiciones frecuentes, lo que optimiza la relación coste/beneficio.
El periodo periparto es crítico para el bienestar materno y neonatal. Los estímulos positivos en este periodo favorecen la conducta maternal, la toma de calostro y la supervivencia del lechón.
Los dispositivos enriquecidos para esta etapa:
Reducen el estrés de la cerda y los movimientos bruscos.
Estimulan el vínculo maternofilial.
Aumentan el tiempo de descanso efectivo de los lechones.
Favorecen la recuperación posparto.

En este caso, Porcsavi ha desarrollado juguetes específicos con aromas y sabores que promueven la atención hacia los lechones, mejoran la interacción positiva con el entorno y favorecen un ambiente de lactación más estable.
La implementación adecuada del enriquecimiento ambiental ha demostrado efectos positivos sobre múltiples indicadores productivos. En condiciones controladas y comerciales, se han documentado las mejoras reflejadas en la Tabla 1:
Indicador Mejora estimada
GMD en engorde +3 a +5 %
Conversión alimenticia (CA) -0,1 a -0,2 puntos
Lesiones por caudofagia -70 a -90 %
Tasa de partos exitosos +5 a +10 %
Mortalidad postdestete -15 a -25 %
Necesidad de tratamientos Reducción significativa
Tabla 1. Mejoras productivas y de bienestar animal reportadas tras la aplicación de programas de enriquecimiento ambiental en condiciones comerciales.
La implementación de enriquecimiento ambiental no es solo una recomendación técnica, sino un requisito normativo progresivamente obligatorio, con plena aplicación en marzo de 2026 según el Real Decreto 159/2023. Las auditorías de certificación (WELFAIR®, IAWS) ya consideran de forma específica la presencia, tipo, funcionalidad y mantenimiento de los materiales de enriquecimiento.
La elección de materiales desarrollados con base científica y adaptados a cada fase productiva, como los fabricados por Porcsavi y AMBiotec, facilita el cumplimiento legal, minimiza el coste operativo y mejora la percepción del producto final por parte del consumidor.

El enriquecimiento reduce la variabilidad entre individuos, lo que permite lotes más homogéneos y predecibles, con mejor planificación de salida al matadero.
El enriquecimiento ambiental en porcino es una herramienta estratégica que permite alinear productividad, sostenibilidad y bienestar animal.
Más allá de cumplir una función etológica, los juguetes funcionales y nutracéuticos ofrecen beneficios fisiológicos tangibles, con repercusiones en la salud digestiva, el comportamiento social y el rendimiento zootécnico.
La innovación desarrollada por empresas como Porcsavi, en colaboración con AMBiotec, ejemplifica cómo el diseño de productos basados en compuestos naturales puede ofrecer soluciones integrales a los retos actuales del sector porcino intensivo.

En AMBiotec colaboramos con PorcSavi, S.L. aportando en el producto Quiet Pig® un núcleo fitobiótico, que otorga a los lechones un plus en su salud y bienestar.

Fabricado a base de antioxidantes naturales para mejorar la microbiota, reduciendo la permeabilidad intestinal.






www.porcsavi.com
www.ambiotecsolutions.com


Emma Fàbrega Romans1, Liza Moscovice2 y Marc Bagaria1
1Programa de Bienestar Animal del IRTA, Monells
2Research Institute for Farm Animal Biology (FBN), Dummerstorf
Durante muchas décadas, el Bienestar Animal se ha abordado desde el ámbito de las Cinco Libertades (FAWC, 1979) que considera que, para conseguir un buen grado de bienestar los animales, estos deben permanecer:
Libres de hambre y sed
Libres de incomodidad
Libres de dolor, enfermedades o lesiones
Libres de miedo o estrés
Libres para expresar sus conductas naturales

CINCO LIBERTADES

Un paradigma más reciente de Bienestar Animal es el que se conoce como el de los 5 dominios (Mellor et al., 1994) en el que existen 4 dominios físicos (salud, ambiente, nutrición y comportamiento), que impactan sobre el dominio mental de los animales, condicionando su estado de bienestar final.
AMBIENTE
Paralelamente a este nuevo marco conceptual, también ha surgido con fuerza el concepto de Bienestar Animal Positivo (Rault et al., 2025).
De manera simplificada, se propone que para conseguir un buen Bienestar Animal no basta con evitar las experiencias negativas, sino que se debería ofrecer la posibilidad de que vivan experiencias positivas.
Dos de los elementos clave en el concepto de bienestar animal positivo son:
1 2
Que los animales puedan experimentar emociones positivas.
Que puedan realizar conductas que les mantengan ocupados de manera positiva.
En la actualidad, se están explorando formas de evaluar de manera objetiva el estado emocional de los animales.

COMPORTAMIENTO MENTAL
A pesar de que está ampliamente aceptado que, tanto humanos como animales, experimentan emociones, el término en sí mismo entraña cierta dificultad para su definición (Russell, J. A., & Barrett, L. F. 1999).
Según el modelo conceptual de (Mendl et al., 2010, 2020), una emoción se refiere a un estado interno del sistema nervioso central de corto plazo ante circunstancias percibidas tanto como positivas o negativas.
Estos mismos autores, adaptaron un modelo de estados afectivos en humanos para animales, dotando a las emociones de un componente de valencia (positivas o negativas) y un componente de actividad (alta o baja) (Figura 1).
SISTEMA DE EVITACIÓN DEL CASTIGO

1. Modelo bidimensional de las características de las emociones (adaptado de Mendl et al., 2010).
Temeroso/a
Ansioso/a
Negativa
Triste
Deprimido/a
A modo de ejemplo, en la Figura 2 se muestran cuatro situaciones en producción porcina donde se podrían experimentar estados emocionales con cada combinación.

Activación alta

negativa



Activación baja
Figura 2. Ejemplos de contextos en producción porcina en cada estado emocional. Q1: cerdos explorando en un entorno favorable (valencia positiva, alta actividad). Q2: cerdos descansando en un entorno adecuado (valencia positiva, baja actividad). Q3: cerda gestante que ha permanecido en una jaula durante un largo período (valencia negativa, baja actividad). Q4: cerda en maternidad antes del parto intentando nidificar (valencia negativa, elevada actividad). (Adaptada de Moscovice, 2024; Fuente fotografías: Q1 y Q2: IRTA; Q3: Wikipedia; Q4: www.freefarrowing.org).
Activación
Alta
Emocionado/a
SISTEMA DE ADQUISICIÓN DE RECOMPENSAS
Feliz
Positiva
Relajado/a
Tranquilo/a
Valencia
Una de las claves en el estudio de las emociones es desarrollar y validar indicadores objetivos para entender si un animal está sujeto a experiencias positivas o negativas.
Entre los indicadores fisiológicos y de conducta asociados con la valencia de las emociones, existen dos que actualmente están recibiendo mucha atención:
El nivel de oxitocina.
Patrones de conducta como la posición y movimientos de la cola.
El objetivo del estudio que se presenta a continuación fue evaluar el impacto del acceso a una zona exterior con materiales manipulables considerados adecuados en la respuesta fisiológica (oxitocina y cortisol) y la conducta para colaborar en la validación de estos dos indicadores en relación al estado emocional en porcino.
El papel de la hormona oxitocina como indicador de estado emocional está en la actualidad en el centro de la discusión (Moscovice et al., 2024).
La oxitocina actúa como un neuropéptido y puede liberarse en el sistema nervioso central en el hipotálamo o a nivel periférico en la glándula pituitaria posterior.

Se le ha atribuido un rol en:
Las interacciones afiliativas.
El reconocimiento social y la memoria.
La reducción de la ansiedad y el miedo.
El desarrollo del parto y la lactación.
La conducta sexual.
(Moscovice et al., 2014)
En la actualidad se llevan a cabo estudios para entender mejor en qué tipo de contextos y ante qué factores de estrés se libera la oxitocina, con la finalidad de mejorar el conocimiento sobre la interacción entre el eje hipotálamohipófisis-adrenal (responsable de respuesta de estrés) y el sistema oxitocinérgico.
A partir de estos estudios se pretende evaluar si la oxitocina podría ser un indicador de la valencia del estado emocional.
Uno de los aspectos relevantes en el estudio de indicadores fisiológicos en la respuesta de estrés o estado emocional, es garantizar que el sistema de toma de muestras no interfiera en los resultados esperados.
De ahí que ha aumentado el uso de la saliva como matriz para evaluar indicadores de estrés como cortisol, por ser menos invasiva que la toma de muestras de sangre (Imagen 1).


Imagen 1. Ejemplo de extracción de muestras de saliva para la medición de cortisol u oxitocina.

Con el fin de evaluar si la oxitocina en saliva podría constituir un buen indicador no invasivo de estado emocional positivo, se realizó un estudio en IRTA-Monells proporcionando acceso al exterior que ha sido previamente validado como un contexto positivo en porcino (Imagen 2).
Evaluamos un total de 20 cerdos machos de engorde Large White x Landrace ubicados en dos salas diferentes y sometidos a un contexto positivo y negativo.
Para crear el contexto positivo para los animales, se le dio acceso al exterior en grupos de 10 cerdos, durante 30 minutos durante 9 días, en un área al aire libre con suelo, hierba y barro.
Se tomaron muestras de saliva y se evaluaron los comportamientos en tres días:
Primer acceso al exterior (día 0)
Contexto positivo (día 7)
Contexto negativo (día 9, acceso al exterior no permitido)

Imagen 2. Cerdos explorando el área exterior tras el acceso al contexto positivo, con suelo natural, hierba y barro, en las instalaciones de IRTA-Monells.
En cada día de muestreo, el comportamiento se evaluó durante 30 minutos pre-estímulo (en el corral principal) y post-estímulo (en el área exterior o en el corral principal para el contexto negativo), realizando:

15 escaneos (postura corporal, postura de las orejas, postura de la cola y movimiento de la cola).
5 minutos de observaciones continuas (agonísticas, afiliativas, juego locomotor, exploración, escapar, excreción y vocalización) para cada cerdo.
Se tomaron muestras de saliva después de evaluar el comportamiento, antes (pre-estímulo) y después (post-estímulo) de llevar a los animales al área exterior (o no en el contexto negativo).
Los resultados del estudio no mostraron diferencias entre los primeros contextos al aire libre, positivo y negativo en cuanto a oxitocina y cortisol en saliva (Gráfica 1).



Gráfica 1. Valores medios de cortisol y oxitocina antes y después del estímulo (acceso a contexto positivo o negativo).
Los cerdos mostraron mayor comportamiento de juego en el primer contexto al aire libre que en el positivo y mayor en el positivo que en el negativo.
Los cerdos exploraron más y mostraron una postura corporal más erguida, con las orejas hacia adelante, moviendo la cola y con la cola levantada en el primer contexto al aire libre y positivo en comparación con el contexto negativo (Gráfica 2).

Gráfica 2. Medias de patrones de comportamiento (movimiento de la cola, juego, exploración, cola levantada, postura erguida y orejas hacia delante) antes y después del estímulo (acceso a contexto positivo o negativo).

Estos resultados están en consonancia con otros resultados del mismo proyecto PIGWEB, todavía no publicados, en los que se han realizado pruebas de validación en cuatro institutos de investigación diferentes.
En este enfoque heterogéneo interinstitucional se ha identificado la postura de las orejas, los movimientos de la cola, la conducta de huida y la conducta de juego como indicadores de valencia positiva o negativa, lo que indica que estas variables pueden identificar estados emocionales en diferentes poblaciones de cerdos en diversos contextos.
Otros supuestos indicadores no invasivos de valencia emocional, como la oxitocina salival, podrían ser más específicos del contexto y podrían estar sujetos a variación ante factores de estrés, pero no necesariamente siempre se produciría un aumento, lo que justificaría una mayor investigación.
Comprender y medir de forma objetiva el estado emocional de los animales es uno de los grandes retos actuales en el ámbito del Bienestar Animal.
El desarrollo y validación de indicadores fiables, ya sean fisiológicos o conductuales, no solo permitirá avanzar en la ciencia del bienestar, sino también aplicar estos conocimientos en entornos de producción real, promoviendo sistemas más respetuosos y adaptados a las necesidades emocionales de los animales.

Desarrollo de indicadores fisiológicos y conductuales de estado emocional positivo en cerdos
DESCÁRGALO EN PDF
Este estudio pertenece al proyecto PIGWEB que ha recibido financiación del programa de investigación e innovación Horizonte 2020 de la Unión Europea (Grant Agreement No 101004770).







Anouk Cottin-Tillon Jefe de Mercado Monogástricos – Jefo

Camadas más grandes, mayor productividad... pero también nuevos desafíos.
En los últimos años, las cerdas hiperprolíficas han revolucionado la cría del cerdo, aportando notables ganancias en eficiencia. Sin embargo, detrás de las cifras prometedoras surgen importantes preocupaciones: partos más largos, lechones más ligeros y una mayor atención necesaria para el bienestar animal.
Este debate arroja luz sobre los costes ocultos de la hiperprolificidad, desde partos prolongados hasta la reducción del peso al nacer, e introduce una solución nutricional específica para ayudar a los productores a optimizar el rendimiento al tiempo que apoya el bienestar de las cerdas y los lechones.

HIPERPROLIFICIDAD: CUANDO LA PRODUCTIVIDAD DESAFÍA EL BIENESTAR
Con más lechones vienen nuevos desafíos: partos más largos, recién nacidos más ligeros, mayor mortalidad y una mayor presión tanto sobre la cerda como sobre el ganadero.
La carrera por la eficiencia está superando los límites biológicos y no se puede ignorar el impacto en la salud, el rendimiento y la rentabilidad de los animales.
Aumento de la duración de los partos
Una de las primeras y más visibles consecuencias de la hiperprolificidad es que los partos duran más.
Como se muestra en la Gráfica 1, existe una clara correlación entre el número de lechones nacidos y la duración del parto.
El parto prolongado es un desafío y un riesgo para las cerdas y sus lechones.
Si el intervalo entre lechones aumenta, se hace necesaria la intervención humana, lo que puede ser un obstáculo y un coste en granjas con mano de obra contratada y/o mano de obra poco cualificada. Además, los lechones nacidos últimos son los que más sufren.
Un estudio de 2023 realizado por Schoos et al. muestra que más allá de 18 lechones, el intervalo aumenta significativamente. Desafortunadamente, los partos más largos aumentan el riesgo de mortalidad para los lechones nacidos al final y los que sobreviven a menudo se debilitan.
Gráfica 1. Relación entre el tamaño de la camada y la duración del parto en cerdas (Peltoniemi et al., 2021).
R2=0,722
Duración del parto (min)
Otra consecuencia del aumento de la prolificidad de las cerdas es la reducción del peso al nacimiento de los lechones.
Un metaanálisis de Moreira et al. (2020) indica que cada lechón adicional reduce el peso al nacimiento en 40 gramos.
Tabla 1. Rendimiento de la cría basado en el peso al nacer de los lechones (Quiniou et al., 2017).
Sabiendo que 100 gramos menos al nacimiento se traducen en 1,5 días más de engorde, las reducciones en el peso al nacer pueden afectar significativamente el rendimiento y la rentabilidad general.
El peso al nacimiento también afecta la supervivencia de los lechones (Gráfica 2).
Se ha demostrado repetidamente que, cuando un lechón pesa menos de 1 kg, sus posibilidades de supervivencia disminuyen significativamente.
Es probable que esto se deba a que los lechones más pequeños son menos vigorosos y menos capaces de competir por los pezones de la cerda.
Peso al nacimiento (kg)
Feldspausch et al., 2019
Quiniou et al., 2002
Furtado et al., 2012
Krahn, 2015
Zotti et al., 2017
Zeng et al., 2018
Gráfica 2. Impacto del peso al nacimiento de los lechones en la tasa de mortalidad antes del destete.
200g
Es crucial que la cerda pueda producir suficiente calostro y leche de alta calidad para satisfacer las necesidades de su camada, especialmente para ayudar a los lechones más pequeños a tener un buen comienzo.
La producción de calostro es un verdadero desafío, ya que el rendimiento de calostro de la cerda no está relacionado con el número de lechones nacidos. Esto significa que cuantos más lechones haya, menos calostro recibirá cada uno.
El calostro no solo es una fuente de protección inmunológica para los lechones, sino que también es su primera fuente de energía.
Esta gran producción tiene consecuencias negativas en la cerda, ya que su metabolismo está sujeto a múltiples tensiones:
Debe adaptarse al estrés del parto y la producción de leche.
Debe adaptarse a un gran cambio en la ingesta de alimento, ya que, la ingesta diaria de alimento de aproximadamente 3 kg durante la fase de gestación se triplica repentinamente durante la lactancia para satisfacer el aumento de las necesidades nutricionales.
En 2012, Quesnel et al. demostraron que la ingesta de calostro está fuertemente relacionada con la mortalidad: por debajo de 200 g de calostro ingerido por lechón, las tasas de supervivencia caen drásticamente (Gráfica 3).
Gráfica 3. Impacto de la ingesta de calostro por lechón en la tasa de mortalidad (Quesnel et al., 2012).
La literatura destaca que la hiperprolificidad es un tema multifacético, que abarca una amplia gama de desafíos (Figura 1).
PROLIFICIDAD
DURACIÓN DEL PARTO
PESO CORPORAL AL NACER
CANTIDAD DE CALOSTRO POR LECHONES

VIGOR DE LOS LECHONES
AGOTAMIENTO DE LA CERDA APORTE ENERGÉTICO INMUNIDAD
PRODUCCIÓN DE LECHE
PESO AL DESTETE
MORTALIDAD ANTES DEL DESTETE
Figura 1. Consecuencias del aumento de la prolificidad.
MORTALIDAD POST-DESTETE
A medida que las demandas de las cerdas hiperprolíficas continúan creciendo, proporcionar un apoyo nutricional efectivo y basado en la ciencia durante el periparto se ha convertido en una palanca clave para ayudar a mantener la condición de la cerda y mejorar los resultados de los lechones.
En este contexto, Jefo ha desarrollado Porcinat POP, una solución nutricional específica diseñada para apoyar a las cerdas alrededor del parto y mejorar la vitalidad de los lechones al destete.
Esta innovadora solución se beneficia de la tecnología Jefo Matrix, una protección adaptada a los cerdos que también facilita la manipulación en la fábrica.
Porcinat POP mejora la duración del parto y el peso al nacer de los lechones, lo que se demostró en un ensayo realizado en una granja francesa y presentado en Nutriforum 2025.

Diseño experimental
Cuatro lotes consecutivos de cerdas
Topigs TN70 se distribuyeron en dos grupos de tratamiento con la dieta proporcionada desde la entrada en la unidad de maternidad hasta el destete:
Grupo testigo: cerdas alimentadas con la dieta control.
Grupo Jefo: cerdas alimentadas con la dieta control + la Solución Jefo.
El número total promedio de lechones nacidos por camada fue similar en los dos grupos (Testigo: 19,3 vs Jefo: 19,2), pero la duración del parto se redujo significativamente (> 1 hora) en las cerdas que recibieron el pienso suplementado con micronutrientes
Jefo en comparación con las cerdas del grupo testigo (Gráfica 4).
Gráfica 4. Duración media del parto
Los resultados mostraron que los lechones nacidos de las cerdas suplementadas con la solución de Jefo también fueron significativamente más pesados que los de las cerdas de control (+ 43 g) (Gráfica 5).
Gráfica 5. Peso medio al nacimiento de los lechones según el tratamiento de las cerdas. 6:00 4:00 2:00 0:00 Duración media del parto (horas:minutos) Tratamiento
El efecto sobre el peso de la camada es visible en la mayoría de los rangos de paridad de cerdas (Gráfica 6). Debido a las limitaciones en el manejo de la granja, solo se pudieron estudiar cerdas multíparas en este ensayo.
Gráfica 6. Peso medio de los lechones según el rango de paridad de la cerda y el tratamiento de la cerda (P (lote x rango) = 0,09). 2 3 Peso medio de los lechones (kg)
Rango de paridad de cerdas
Jefo
La suplementación de las cerdas con la solución Jefo redujo significativamente la duración del parto y mejoró el peso al nacimiento de los lechones.
La combinación de estos dos factores permite a los lechones tener un mejor comienzo y mejora el peso de la camada al destete (Gráfica 7).
La suplementación dietética con la solución Jefo ha demostrado ser eficaz para reducir la duración del parto y mejorar el peso al nacimiento de los lechones. Estas mejoras ofrecen una ventaja tangible en el manejo de cerdas hiperprolíficas, asegurando mejores resultados desde el nacimiento hasta el destete, al tiempo que salvaguardan tanto el rendimiento como el bienestar.
Para obtener más información sobre esta solución y discutir el soporte para gestionar la hiperprolificidad, los equipos de Jefo están disponibles: contact.europe@jefo.ca
Testigo Jefo
Gráfica 7. Peso medio de la camada destetada.
Bories et al. (2010) demostraron que la duración del parto se correlaciona con el peso total de la camada. En nuestro estudio, pudimos demostrar que este parámetro se puede mejorar a través de la suplementación dietética de Jefo.
Las cerdas del grupo Jefo mostraron pérdidas de grosor de grasa dorsal similares a las del grupo Testigo. Así, estas cerdas lograron movilizar la misma cantidad de energía corporal a pesar de un aumento numérico en el peso de la camada destetada.

Cerdas hiperprolíficas: ¿pueden coexistir el rendimiento y el bienestar?
DESCÁRGALO EN PDF
Reduce la duración del parto
Optimiza el peso al nacimiento y al destete
Reduce el estrés para ambos, cerdas y lechones
El destete es uno de los momentos más críticos en la producción porcina. Durante esta etapa, los lechones se enfrentan a cambios importantes en su alimentación y entorno que pueden afectar significativamente su crecimiento y salud.
La transición desde la leche materna a una dieta sólida supone un estrés fisiológico y metabólico que, si no se gestiona adecuadamente, puede traducirse en un retraso en el crecimiento, mayor incidencia de enfermedades y un aumento de los costes para el productor.
El destete implica la separación del lechón de la cerda y el cambio de alimentación, lo que puede provocar:
Alteraciones en la ingesta
Estrés
Vulnerabilidad frente a enfermedades

Tradicionalmente, la alimentación en esta fase se hacía de manera uniforme, sin diferenciar las necesidades específicas de cada grupo, lote o fase, lo que puede provocar problemas nutricionales (diarreas) y desperdicio de pienso.
Por ello, el sector demanda sistemas que permitan una alimentación más flexible, precisa y adaptada a la evolución fisiológica de los animales.
El sistema multifase cumple esta función al dividir el destete en diferentes etapas nutricionales, cada una con una alimentación específica que:
Maximiza la digestibilidad
Optimiza el aprovechamiento de nutrientes
Reduce el impacto ambiental (emisiones, etc.)
iQon Multifast™?
iQon Multifast™ es una solución tecnológica desarrollada por Roxell y distribuida por New Farms, diseñada para ofrecer una alimentación flexible, precisa y rápida.
Es el sistema más rápido del mercado, capaz de manejar hasta 7.000 kg/h, lo que lo hace ideal para explotaciones de cualquier tamaño que busquen optimizar tiempos y rendimiento.
Este sistema permite mezclar varios alimentos o ingredientes en dosificaciones muy precisas, adaptando la ración a cada animal o grupo (lote) según sus necesidades en cada fase del ciclo de vida.
Está compuesto por dos elementos clave:
Sistema de control y pesaje automático Control Line/Weigher-Mixer:
Con báscula mezcladora de 100 o 200 litros en acero inoxidable y celdas de carga, permite dosificar y mezclar hasta 20 ingredientes diferentes y gestionar hasta 50 curvas de alimentación.
Esto posibilita una nutrición individualizada por corral, sala, o tolva.


Salidas automáticas iQon
Báculamezcladora

Línea de transporte Flex Line/ Flex-Auger:
Transporta el pienso de forma rápida, precisa, y sin atascos.
Su diseño evita roturas de gránulos y la adhesión del pienso en las paredes del transportador, garantizando la descarga completa mediante bocas automáticas electrónicas.


Almacenamiento de pienso
Unidad de control central
Sistema de transporte de pienso
Alimentación progresiva y personalizada: evita cambios bruscos en la dieta, reduciendo el estrés y mejorando la adaptación digestiva (evitando diarreas).
Reducción de residuos y emisiones: disminución de las deyecciones, disminuyendo el amoníaco, fósforo y nitratos, favoreciendo la sostenibilidad.
Mayor e ciencia y rendimiento: mejora de los índices de conversión y el peso diario medio, optimizando cada gramo de pienso suministrado. Reducción de costes de alimentación.
Rapidez y abilidad: transporte por lotes individuales con caudal de hasta 7.000 kg/h y sin interrupciones.
Control total y trazabilidad: monitoriza el consumo por kg/animal, controla el contenido nutricional, la tasa de crecimiento y el tiempo de alimentación.
En Aitona, New Farms está instalando en un proyecto nuevo de destete el sistema multifase iQon Multifast™, con la finalidad de implementar todas las ventajas descritas anteriormente. Aunque el proyecto está en proceso, ya se están sentando las bases para una gestión de la alimentación mucho más precisa y eficiente.
El sistema permitirá adaptar las raciones desde el primer día del destete hasta la salida de los lechones, ajustando la formulación y cantidad según la evolución de cada grupo o sala.
Esta flexibilidad es clave para mejorar la salud y el crecimiento de los animales y para optimizar los recursos y, por ende, los costes
La combinación con los sistemas de climatización más avanzados crea un entorno ideal para los animales, aumentando su bienestar y minimizando el impacto de condiciones adversas.
La implementación de estos sistemas supondrá un salto cualitativo en la producción porcina, obteniendo unos resultados que se traducirán en mejoras visibles tanto en la salud animal como en la rentabilidad de la explotación.
Manejo y supervisión sencillos: control remoto desde PC o internet con visualización grá ca e historial de datos.
Versatilidad en instalación: compatible con silos o tolvas de día, espirales FA90 o FA125, y cadena Disca ex.


Para aquellas explotaciones que buscan optimizar el destete, mejorar el bienestar animal y maximizar la eficiencia productiva, optimizando costes, el sistema de alimentación multifase es una herramienta imprescindible.
Para más información sobre el sistema multifase y su implementación, no dudes en contactar con New Farms.
Evolución en la alimentación de los destetes: el sistema iQon Multifast™ lo hace posible DESCÁRGALO EN PDF
Control preciso de todo el proceso de alimentación, desde que el pienso sale de los silos hasta que llega a las tolvas o dosificadores. De esta forma se garantiza una óptima y precisa dosificación y racionalización del alimento, con cambios progresivos y suaves, además de un ahorro en costes y con el mejor bienestar posible.

Distribución de la alimentación flexible y a medida para cada granja, con ración óptima y precisa, adecuada según necesidades.



Transiciones graduales con óptima adaptación digestiva.
Mezcla precisa de hasta 20 tipos de alimento opienso, y hasta 50 curvas de alimentación.
de alimentación multifase Camí de Flix, s/n 25186 LLARDECANS Lleida - España Tel: +34 973 13 02 92
Transporte general con espirales de 90, el más rápido del mercado
Manejo y control sencillo y a distancia.
Ahorro de pienso, con óptimas conversiones, y con menos desperdició y emisiones.
Descubre cómo implementar el sistema multifase en tu granja.
new-farms@new-farms.com www.new-farms.com

Departamento técnico de PRODUMIX
En la producción porcina moderna, el concepto de eficiencia ha evolucionado desde una mera referencia a la conversión alimenticia hasta convertirse en un principio rector que abarca múltiples dimensiones como por ejemplo rentabilidad económica, sostenibilidad ambiental, bienestar animal, salud intestinal y uso racional de antibióticos.
En un entorno donde las exigencias regulatorias, sociales y de mercado son cada vez mayores, alcanzar y sostener altos niveles de eficiencia nutricional no es una opción, sino una necesidad estratégica.
Este artículo explora cómo una nutrición porcina basada en la eficiencia permite al productor cumplir con los desafíos actuales de la industria, manteniendo la productividad sin comprometer la salud animal ni el entorno.



Resistencia antimicrobiana: unproblemadesaludpública, económico y social
La resistencia bacteriana a los antibióticos (RAM) ha sido reconocida por la OMS como una de las mayores amenazas para la salud pública mundial. Se estima que, de no tomarse medidas, para el año 2050 podrían morir hasta 10 millones de personas al año por infecciones resistentes a antibióticos comunes (O’Neill, 2016; OMS, 2020).
Esta amenaza no solo tiene implicaciones sanitarias, sino también económicas (por los costes crecientes del tratamiento, días de trabajo perdidos, menor productividad, etc.) y sociales, por la desconfianza generada en el consumidor hacia los sistemas de producción intensiva.
Según la FAO, la ganadería es responsable de aproximadamente el 14.5% de las emisiones globales de GEI (gases efecto invernadero) relacionadas con las actividades humanas (7 gigatoneladas de CO₂-eq).
La producción porcina representa el 9,7% de las emisiones ganaderas globales, o dicho de otra forma, el 1,4% de las emisiones globales generando aproximadamente 0,7 gigatoneladas de CO₂-eq por año.
La percepción social y las regulaciones exigen prácticas de manejo que minimicen el estrés, el dolor y la incomodidad, sin comprometer el rendimiento productivo. Según el Código Terrestre de la Organización Mundial de Sanidad animal, el bienestar animal designa “el estado físico y mental de un animal en relación con las condiciones en las que vive y muere).
Esta definición incluye las “cinco libertades” (Informe Comité Brambell; Reino Unido 1965) según las cuales un animal debe estar:
Libre de hambre, sed y desnutrición.
Libre de incomodidades físicas o térmicas.
Libre de dolor, lesiones y enfermedades.
Libre de miedo y angustia.
Libre para expresar un comportamiento normal.
Producción de piensos
3.3 Gigatoneladas
3.5 Gigatoneladas
Producción ganadera Transporte y procesamiento posterior a la granja
Productos no destinados a la alimentación
Monogástricos Rumiantes
1.3 Gigatoneladas 5.7 Gigatoneladas
Huevos
1.2 Gigatoneladas
Carne de pollo
1.4 Gigatoneladas
Carne de cerdo
0,7 Gigatoneladas


Leche y carne de búfalo
0.6 Gigatoneladas
0.2 Gigatoneladas
Subproductos del matadero
Estiércol disponible para aplicación en cultivos no destinados a la alimentación
1.4 millones de toneladas de N
Tracción, fibra y estiércol usado como combustible
0.4 Gigatoneladas
Carne de vacuno
0.9 Gigatoneladas
Leche de vaca
1.4 Gigatoneladas
Pequeños rumiantes (leche y carne)
0.4 Gigatoneladas
Figura 1. Emisiones de GEI de las cadenas de suministro ganaderas mundiales, por actividades de producción y productos.
La rentabilidad se ve cada vez más condicionada por las exigencias del mercado, que valora productos más éticos, sostenibles y seguros.
Hoy más que nunca, se reconoce la interconexión entre la salud de los animales, las personas y el medio ambiente.
El enfoque One Health implica entender que las decisiones que tomamos en nutrición animal afectan directamente la resistencia antimicrobiana, la inocuidad de los alimentos, la salud de los ecosistemas y la seguridad sanitaria global.
La eficiencia, en este contexto, permite producir más con menos y con menor riesgo.
En el contexto actual, ser eficiente no es simplemente una meta productiva, sino una estrategia integral que permite abordar múltiples objetivos simultáneamente y es por ello que la podríamos definir como:
“Capacidad de lograr los mejores resultados posibles con el uso óptimo de recursos, maximizando

La eficiencia, bien entendida, no se limita a lograr una buena conversión alimenticia, sino que implica:
Rentabilidad: menor coste por kilo producido
Sostenibilidad: menor uso de insumos y menor impacto ambiental
Bienestar animal: alimentación más ajustada reduce el estrés y mejora la salud
Imagen y licencia social: los sistemas eficientes son más respetuosos, transparentes y alineados con las demandas del consumidor
La nutrición de precisión busca adaptar la dieta al animal de manera individualizada. Esto implica dos conceptos clave:
Exactitud: conocer con el mayor grado de certeza posible lo que realmente necesita el animal.
Precisión: adaptar el suministro de nutrientes a la variación individual (curva de crecimiento, estado fisiológico, consumo real, rendimiento, etc.).
Para lograrlo, hay que aplicar varios conceptos como, por ejemplo:
Formulación y ajuste nutricional (dinámica, req. nutricionales, modelos matemáticos, microbiota, condiciones producción, personalizada, etc.)
Tecnología y monitoreo (automatización, sistemas alimentación, básculas, cámaras, sensores, RFID, Big Data, IA, investigación, etc.)
Aditivos funcionales (enzimas, ácidos, probióticos, prebióticos, extractos de planta, aceites esenciales, gluconeogénicos, etc.)
Procesos de fabricación de alimentos (microencapsulación, NIRS, peletización, “blend-on-demand”
En definitiva, implementar todo aquello que nos permita “Suministrar a cada cerdo, en el momento oportuno, la cantidad y calidad exacta de nutrientes necesarios para optimizar su crecimiento, salud, bienestar animal, eficiencia productiva y sostenibilidad.”
A continuación, podemos ver el potencial que tiene la implementación de nutrición de precisión en el estudio titulado “Precision feeding can significantly reduce lysine intake and nitrogen excretion without compromising the performance of growing pigs”, Andretta et al. (2016) demostraron que la aplicación de estrategias de alimentación de precisión permite:
Reducción del 26% en el consumo de lisina
Mejora en la eficiencia de uso de lisina del 53,3% al 70,9%
Disminución de la excreción de nitrógeno en un 30% y fósforo en 17%
Mantenimiento resultados productivos
Reducción del coste de alimentación en $7,60/cerdo (-10% costo alimentación)
Menor coste por kg de ganancia (-6%)
Cuando se logra exactitud (saber lo que necesita el animal) y precisión (ajustar la entrega de nutrientes) se permite reducir los costos de alimentación, mantener o incluso mejorar los parámetros productivos, y avanzar hacia una producción más sostenible.
Además, la tecnología (RFID, software, cámaras, etc.) permite monitorizar el comportamiento individual de cada cerdo y sus patrones de consumo.
Esto facilita la detección temprana de enfermedades antes de la aparición de signos clínicos visibles, ya que uno de los primeros indicadores de malestar es la disminución del apetito.
Esta capacidad de diagnóstico precoz permite intervenir rápidamente: tratar al animal, aislarlo si es necesario y evitar la propagación de la enfermedad. Todo ello contribuye a mejorar el bienestar animal y, al mismo tiempo, a reducir los costes sanitarios y productivos.
¿QUÉ HACER CUANDO NO SE DISPONE DE TECNOLOGÍA AVANZADA?
La repuesta es “Aspirar a la mayor precisión, exactitud y realismo posibles dentro de nuestras capacidades”.
En cuanto a la nutrición el objetivo tiene que ser diseñar e implementar un programa nutricional que sea lo más exacto y preciso posible.
Programa nutricional = Formulación (exactitud) + Manejo de alimentación (precisión)
Para ello, entre otras cuestiones, es clave trabajar sobre los siguientes elementos:
Medición del consumo y resultados: pesar alimento, monitorizar GMD, IC, peso final, coste kg repuesto, etc.
Curvas de crecimiento y alimentación: adaptadas a la genética, fase, condición corporal, objetivos productivos.
Información de materias primas:
Composición (NIRS, tablas ajustadas).
Calidad (micotoxinas, enranciamiento,etc).
Coste.
Diseño de programas específicos por sitio: genética, instalaciones, sanidad, etc.





Implementación curva alimentación cerdas en granja de 1400 madres durante el año 2020 basada en etapa gestacional, paridad de la cerda, medición de espesor de grasa dorsal (EDG) con ecógrafo y resultados productivos.
Gracias a la implementación de la curva de alimentación durante el año 2020, se consiguió los siguientes resultados:
Ahorro superior a $24.000 anuales en consumo de alimento.
Mejor condición corporal durante la gestación.
Aumento del consumo de alimento durante la lactancia.
Aumento del consumo durante el intervalo destete-cubrición.
Tabla 1: Consumo de alimento 2019 vs 2020.
Tabla 2. Resumen principales resultados técnico-económicos granja 2019 vs 2020.

Actualización de formulación en programas nutricionales de cerdos de engorde.
En el siguiente cuadro tenemos un resumen con los requerimientos nutricionales (tablas brasileñas 2024) para cerdos en la etapa de desarrollo (91-119 días de vida de los cerdos o de 50 a 80 kg de peso vivo).
Tabla 4. Requerimientos nutricionales para cerdos en etapa de desarrollo, de acuerdo con las Tablas Brasileñas de Nutrición Animal (2024).
En este caso tenemos dos fórmulas (A y B) que a nivel nutricional los niveles de aminoácidos digestibles y la relación de proteína ideal son similares a lo que estamos buscando en la tabla anterior. La fórmula A presenta un mayor nivel de proteína bruta, grasa bruta y un exceso en los ratios val dis:lys dis e iso dis:lys dis).
Tabla 3. Resumen principales resultados técnico-económicos lechón 2019 vs 2020.
Además del ahorro económico producido por la optimización del consumo de alimento por parte de las cerdas, se consiguió mejorar la mayoría de los parámetros productivos tanto en las cerdas como en los lechones y reducir el coste por lechón y por kg producido de lechón destetado.
En resumen, se produjo de manera más rentable y con mayor bienestar animal.
Tabla 5. Comparación de dos fórmulas (A y B), cuyos niveles de aminoácidos digestibles y relación de proteína ideal se aproximan a los valores de referencia presentados en la tabla anterior.
Para alcanzar esto niveles nutricionales, la fórmula A, al no contar con la inclusión en este caso de triptófano y valina, tiene que incorporar una mayor cantidad de harina de soya para llegar a los niveles de aminoácidos requeridos para esta etapa y, además, para mantener los niveles de energía, tiene que incorporar una mayor cantidad de aceite lo que a nivel económico significa un aumento en los costes (+$11,69/Ton).
Ingredientes
Maíz
Aceite de palma 2,05% 1,30% 0,75%
Calcita 0,85% 0,80% 0,05%
Biofos 0,60% 0,65% -0,05%
Sal 0,50% 0,50% 0,00%
Vit-Min 0,40% 0,40% 0,00%
Lisina HCL 0,16% 0,42% -0,26%
Secuestrante 0,10% 0,10% 0,00%
L-Treonina 0,05% 0,17% -0,12%
L-Tiptófano 0,80% 0,04% -0,04%
L-Valina 0,70% 0,04% -0,04% Total 100,00% 100,00%
Tabla 6. La fórmula A requiere mayor inclusión de harina de soya y aceite, lo que incrementa el costo en 11,69 USD.
Si esta información la extrapolamos a una granja que produce 12.500 cerdos en el año, con un consumo de 30 kg por cerdo para esta etapa, estaríamos hablando de un total de 750 toneladas de alimento. Abajo podemos observar el impacto comparado entre la fórmula A y la fórmula B tanto a nivel de sostenibilidad como a nivel económico:
PB enviada 21,825 kg <necesidad ingredientes proteicos
N no excretado 3,492 kg N =775 personas/año < Riesgo eutrofización
Emisiones NH 3 evitadas 1.920,6 kg NH 3 =960 cerdos/ciclo eng
Huella de carbono 47.142 kg CO 2 eq =plantar 2.140 árboles ≈ 10 coches/año ≈ 190 cerdos eng
Reducción harina soya 64.200 kg 224.700 kg CO 2 eq ≈ emisiones 50 coches/año
Ahorro económico $ 8.767,50 Sólo una etapa (25%)
Tabla 7. Impacto comparado entre fórmula A y fórmula B (12.500 cerdos y 750 Ton de alimento).
En resumen, simplemente por el hecho de ajustar la formulación podemos producir de una manera más eficiente, rentable y sostenible.
La nutrición porcina es, sin duda, un aliado clave en la evolución de la industria. Aplicada con precisión y exactitud, permite responder a los grandes retos actuales y futuros:
Reducir costes y mejora del margen económico (rentabilidad).
Minimizar el impacto ambiental por unidad de carne producida (sostenibilidad).
Animales mejor nutridos, más sanos y menos estresados (Bienestar animal).
En definitiva, la evolución no vendrá de hacer más de lo mismo, sino de hacerlo
mejor: con conocimiento, exactitud, precisión y compromiso.
Nutrición porcina: aliado clave en la evolución de la industria DESCÁRGALO EN PDF


Las soluciones nutricionales más adecuadas para optimizar la rentabilidad en cada condición productiva
















+6,3% peso de CAMADA -0,67 días de intervalo DESTETE +2,8% Ganacia media diaria -3,3%




IC que otros programas nutricionales +500 gr/lechón destete a 70 días +16% más de homogeneidad






IC que otros programas nutricionales +1,45 kg durante el periodo de engorde +1% mejora del coste de producción




David García Páez
Especialista en Bioseguridad Aplicada en OneSilex

NUEVA FRONTERA EN LA BIOSEGURIDAD
“Ojos que no ven, corazón que no siente…”
Esta frase, dicha sin malicia en tantas granjas, es la misma piedra con la que tropezamos una y otra vez: interior de las líneas de pienso, tuberías que serpentean bajo el hormigón, silos con pienso apelmazado en su cono y en sus ondulaciones, rincones húmedos sin luz con planchas de aluminio o PVC donde se alojan infinidad de insectos como las cucarachas, cada vez más presentes en todas las granjas porcinas de España.

Los patógenos —bacterias, virus, hongos y esporas— se han vuelto maestros de la invisibilidad, prosperando en esos rincones donde el ojo humano, nunca llega o mejor dicho no quiere llegar.

La bioseguridad, lejos de ser una mera lista de protocolos y productos por aplicar o un checklist a cumplimentar por las, cada vez más grandes, integradoras para las grandes marcas en los supermercados, se ha consolidado como la columna vertebral de cualquier explotación porcina moderna que aspire, ya no solo a la excelencia, sino a tener bajo mínimos los riesgos controlados en un umbral que sea económicamente viable.
Se trata de:
Evitar la entrada de enfermedades.
Salvaguardar la rentabilidad.
Asegurar la calidad del producto final.
Proteger la salud pública de la cadena alimentaria y la de los trabajadores se dan cita a diario en las explotaciones.
El mercado actual no solo exige animales sanos y eficientes, sino que demanda una liturgia de seguridad alimentaria con trazabilidad y verificada de principio a fin.
Cada animal que sale de la granja arrastra tras de sí, para bien o para mal, el histórico de la limpieza y desinfección, así como del manejo en su entorno.

Estas prácticas L+D han evolucionado, pero aún persisten desafíos significativos, siendo uno de los mayores errores en la gestión sanitaria, asumir que lo que no se ve, no afecta.
Muchos de los focos de contaminación más persistentes están ocultos y pueden acantonarse, permaneciendo activos durante semanas o meses si no se implementan medidas específicas de control.
Las zonas visibles (corrales y boxes, pasillos, tolvas externas, por ejemplo) suelen recibir atención regular, las zonas ocultas o con acceso complicado quedan frecuentemente fuera del protocolo.
Esto crea microambientes ideales para la proliferación de patógenos, con consecuencias sanitarias y productivas más que significativas para la explotación y, por ende, para la integración.
Es por ello por lo que proponemos un viaje de 360° por la bioseguridad: desde las barreras visibles que frenan la entrada de enfermedades hasta los reservorios internos que, si no se desactivan, reescriben cualquier protocolo, poniendo en jaque todo el esfuerzo productivo y económico.
Un programa de bioseguridad robusto se estructura en dos niveles complementarios que actúan como un doble escudo protector para la granja, bioseguridad externa y bioseguridad interna, cada una con su propia lógica y conjunto de medidas, pero intrínsecamente interconectadas para formar una defensa lo más impenetrable posible.
BIOSEGURIDAD EXTERNA: LA FORTALEZA Y SU FOSO
El objetivo de la bioseguridad externa es claro y primordial: evitar que los agentes infecciosos, ya sean virus, bacterias, hongos o esporas, parásitos o insectos, entren en la explotación.
Actúa como la primera línea de defensa y se centra en controlar todos los puntos de acceso con el exterior.
UBICACIÓN Y PERÍMETRO: LA PRIMERA DECISIÓN ESTRATÉGICA
Pensemos en la granja como una fortaleza. El foso —distancia física, caminos controlados, cercas— marca la primera línea de defensa.

La localización de la explotación es, de hecho, la primera decisión de bioseguridad.
3-5 km
Idealmente, debería estar a una distancia considerable de otras explotaciones porcinas (se recomienda un mínimo de 3 km a 5 km para reducir el riesgo de transmisión aérea o por vectores voladores o rastreros) y de vías de alto tránsito de circulación.
Un cercado perimetral completo y bien mantenido es indispensable para:
Delimitar la propiedad.
Impedir la entrada de animales silvestres (como jabalíes, vector clave en la transmisión de enfermedades como la Peste Porcina Africana - PPA)








CONTROL DE ACCESOS: EL FILTRO HUMANO Y VEHICULAR
“El acceso a la granja debe ser un privilegio, no un derecho”.
Se debe limitar al máximo la entrada de personas y vehículos, y todo acceso debe ser registrado y seguir un protocolo estricto.
El personal y las visitas esenciales deben someterse a un riguroso protocolo de ducha y cambio a ropa y calzado de uso exclusivo de la granja.

Es fundamental establecer un periodo de vacío sanitario (generalmente 2448 horas) desde el último contacto con otros cerdos o explotaciones. 24-48h
Los vehículos representan un vector de riesgo considerable.
Deben existir zonas de aparcamiento externas para visitas y para la descarga inicial de suministros.
Los vehículos que necesiten entrar en la zona limpia de la granja deben pasar obligatoriamente por un arco de desinfección que contacte con toda la superficie de este, haciendo hincapié en las ruedas y bajos con desinfectantes específicos y que puedan actuar en condiciones de alta cantidad de materia orgánica.
diezmar un lote, y este al siguiente, y así sucesivamente. Ya saben, una vez que el patógeno entra, controlarlo resulta muy difícil.
INTRODUCCIÓN DE ANIMALES Y GENÉTICA: EL CABALLO DE TROYA
La entrada de nuevos animales en la granja es, sin duda, uno de los mayores riesgos sanitarios.
Cada cerdo entrante es un potencial “Caballo de Troya”, capaz de introducir enfermedades latentes o subclínicas que pueden pasar desapercibidas en una inspección superficial.

al de nuestra propia explotación.
Una cuarentena estricta y aislada para todos los animales nuevos es innegociable, con chequeos serológicos y clínicos exhaustivos antes de su introducción al núcleo principal.
El pienso y el agua son elementos vitales para la producción y también pueden ser vehículos insospechados de patógenos si no se manejan con la debida precaución.
Se debe trabajar con proveedores de confianza que garanticen la calidad y seguridad de sus productos.
Los silos de pienso y los depósitos de agua deben estar protegidos de la contaminación externa, con tapas seguras o lonas, filtros de aire adecuados y sistemas de ventilación que eviten la condensación, sobre todo de gases de productos biocidas, que son altamente perniciosos para la salud humana.
La retirada de cadáveres y purines, por su naturaleza, son operaciones de alto riesgo que requieren una planificación meticulosa y que deben realizarse desde puntos perimetrales de la granja, idealmente con contenedores o fosas accesibles desde el exterior de la explotación, pero nunca desde el acceso interno a estas. En cuanto a la genética, la adquisición de semen debe realizarse exclusivamente a centros de inseminación con las más altas garantías sanitarias. Y es que los mejores genes pierden brillo si llegan acompañados de PRRS, Circovirus o cualquier otra enfermedad que comprometa la salud y la productividad de la descendencia.


Una vez que las barreras externas están aseguradas, la bioseguridad interna se enfoca en limitar la propagación de aquellos patógenos que ya puedan estar presentes en la granja, o que hayan logrado sortear las defensas externas.
Nuestro lema debe ser “controlar el movimiento para proteger a los animales más vulnerables y evitar la recirculación de enfermedades”.

Prelimpieza, tratando de eliminar en la mayor medida posible, la materia orgánica gruesa.
FLUJO DE PRODUCCIÓN “TODO DENTRO - TODO
FUERA” (TD-TF): LA PIEDRA ANGULAR
Este sistema es la piedra angular de una bioseguridad interna efectiva y, a menudo, la medida más impactante en la reducción de la presión de posibles infecciones.
Consiste en manejar a los cerdos en lotes de la misma edad, moviéndolos juntos a través de las distintas fases productivas y, crucialmente, vaciando, limpiando y desinfectando completamente cada sala antes de la entrada del siguiente lote.
La secuencia es tan familiar como indispensable:

Limpieza en húmedo, aplicando el detergente en forma de espuma alcalina con el objetivo de emulsionar la parte grasa de la materia orgánica adherida y disolver su parte soluble.


1 2 3 4 5


Aclarado o enjuague posterior, a alta presión, para vehicular los residuos.

Con la superficie completamente seca (fundamental para la eficacia de los desinfectantes), la desinfección en forma de espuma activa ya sea, ácida o no, según el patógeno objetivo y las características del agua.

FLUJO DE PERSONAS Y MATERIALES:
El trabajo diario dentro de la granja debe seguir un flujo lógico y unidireccional: desde las zonas más limpias y los animales más jóvenes (maternidades, transiciones) hacia las zonas más sucias y los animales de más edad (cebos).
¡Nunca a la inversa sin volver a pasar por las medidas de higiene requeridas!
“Pierdo tiempo”, dirá el operario novel, pero gana coherencia sanitaria y evita la diseminación de patógenos de áreas de mayor carga a áreas de menor carga.
Se deben usar materiales (botas, monos, herramientas) específicos para cada área, idealmente diferenciados por colores para una identificación rápida y visual.
El utillaje codificado y la señalética son detalles que marcan la diferencia: cubos y palas rojas para transición, azules para gestantes, verdes para cebo.
Puede parecer un detalle menor, casi nimio, pero, créanme, cuando un brote de Lawsonia golpea, ese “arcoíris cromático” en las herramientas puede ser la diferencia entre un susto y un

SANITARIO
ANIMALES: MINIMIZANDO LA TRANSMISIÓN DE PATÓGENOS
Las prácticas de manejo diario tienen un impacto directo en la bioseguridad.
Minimizar el movimiento de lechones entre camadas (adopciones cruzadas), especialmente durante brotes de enfermedades como el PRRS, es fundamental para contener la diseminación.
El uso de agujas individuales por animal o, como mínimo, por camada, es una práctica esencial para evitar la transmisión iatrogénica de enfermedades.
La identificación temprana y el aislamiento de animales enfermos en enfermerías dedicadas, así como la correcta eliminación de cadáveres según los protocolos establecidos,











SILENCIOSOS
Un plan sistemático y proactivo para el control de roedores (Rattus rattus y Mus musculus), insectos (moscas, mosquitos, cucarachas) y aves silvestres, es vital.
Estas plagas actúan como vectores mecánicos y reservorios de múltiples enfermedades, transportando patógenos de un área a otra o incluso de granjas vecinas.
La implementación de cebos rodenticidas en estaciones seguras y siempre ajustadas al tipo de especie que tenemos en la explotación (no todas las trampas se deben o pueden colocar en el suelo, los pasillos y cerca de las tolvas, sino por el lugar de paso, aunque también pueden colocarse en alto, por ejemplo, en tuberías aéreas o cables eléctricos), las trampas de insectos, las mallas pajareras en ventanas y aberturas, y programas de control de vectores debe ser constantes y adaptados a las condiciones estacionales y

En esta primera parte hemos recorrido las claves de la bioseguridad externa e interna, entendida como la auténtica fortaleza que protege frente a la entrada de agentes infecciosos y limita su propagación dentro de la granja. Desde la ubicación estratégica y el control de accesos hasta la gestión de suministros, flujos de animales y personas o el control de plagas, se ha puesto de manifiesto que la disciplina no es un mero protocolo, sino la columna vertebral de la sanidad y la rentabilidad.
En la segunda parte daremos un paso más allá para adentrarnos en los rincones menos evidentes: los reservorios ocultos donde los patógenos encuentran refugio y desde los que pueden comprometer todo el esfuerzo previo.

Bioseguridad porcina 360°: de las barreras visibles a los reservorios ocultos - Parte I DESCÁRGALO EN PDF
Equipo técnico Bbzix

Los lechones, en sus primeras semanas de vida, se enfrentan a diversos desafíos, especialmente relacionados con su sistema digestivo inmaduro.
Durante el destete y la transición a la alimentación sólida, los lechones son susceptibles a trastornos digestivos y enfermedades gastrointestinales que afectan su bienestar y rendimiento.
La acidificación del agua ha demostrado ser una estrategia efectiva para mejorar la salud digestiva de los lechones:
Optimizando su desarrollo
Promoviendo una transición más suave hacia la alimentación sólida
Reduciendo la incidencia de enfermedades
Los ácidos orgánicos e inorgánicos se añaden al agua en concentraciones específicas, generalmente entre el 0,1% al 1% del volumen total del agua consumida por los lechones en función del objetivo de pH en agua deseado y los resultados productivos que se buscan.
Por lo general, el pH del agua de bebida que se suele trabajar para los lechones se sitúa de 4 a 5,5.


continua o durante ciertos períodos críticos, como en este caso (la transición) o cuando se detecta un brote de enfermedades gastrointestinales en la granja.
La acidificación del agua consiste en la adición de una sustancia acidificante (ácido), capaz de liberar átomos de hidrógeno (H+) a un medio para variar su pH (disminuyéndolo).
En el mercado es común trabajar con ácidos orgánicos e inorgánicos en función de los objetivos que se quieran conseguir.
orgánicos
Los ácidos orgánicos contienen carbono (C), cadenas de carbohidratos (CH 3) y se caracterizan por tener un grupo funcional carboxilo (-COOH). Este tipo de ácidos proviene de fuentes biológicas.
Estos ácidos son más débiles en comparación con aquellos con pKa más alto, con un poder de disociación más bajo y por eso, tienen la capacidad de llegar al tracto digestivo en estado no disociado, es decir tienen acción directa en el intestino.
Entre los ácidos orgánicos más comunes utilizados para la acidificación del agua están el ácido fórmico, ácido láctico, ácido acético, cítrico, ácido propiónico, entre otros.


El uso en continuo y a grandes dosis de ácidos orgánicos tienen el inconveniente de favorecer la presencia de biofilm en las tuberías, produciendo contaminaciones en el agua y obstrucciones de bebederos.
Los ácidos inorgánicos con pKa bajo son aquellos cuya constante de disociación ácida es pequeña, lo que significa que se disocian fácilmente en el medio, liberando protones (H+). Los ácidos inorgánicos se disocian totalmente en una solución acuosa y no tienen capacidad para llegar a nivel intestinal.
Estos ácidos no tienen acción a nivel intestinal, puesto que ya se han disociado anteriormente, terminando su acción a nivel estomacal. Los ácidos inorgánicos más utilizados son el fosfórico, clorhídrico, sulfúrico, entre otros.

El uso de ácidos inorgánicos no favorece la presencia de biofilm y es capaz de desincrustar deposiciones de calcio en tuberías.
Como su propio nombre indica, la acidificación del agua implica la adición de dichos ácidos al agua de bebida de los lechones para conseguir dos funciones con sus correspondientes beneficios:
En el caso del uso del cloro para desinfectar un tipo de agua con un pH superior a 6,5, la disociación del ácido hipocloroso no se producirá y la capacidad de desinfección del cloro adicionado será prácticamente nula.
Es por ello por lo que, se adicionan ácidos al agua que se trata con cloro para mejorar la capacidad desinfectante del cloro.
Mejora de la digestión y absorción de nutrientes
Un agua más ácida favorece la activación de las enzimas digestivas en el tracto gastrointestinal de los lechones, mejorando la descomposición de los alimentos y la absorción de nutrientes.
La acidificación del agua ayuda a activar la pepsina, una enzima clave para la digestión de las proteínas. Con una digestión más eficiente los lechones pueden aprovechar mejor los nutrientes de los alimentos y, como resultado, presentar un mayor crecimiento y desarrollo.
El páncreas es el responsable de producir estas enzimas, pero las libera al tracto digestivo en forma de zimógenos, forma inactiva de las enzimas.
La acción del ácido clorhídrico producido en el estómago acidifica el bolo alimenticio y hace que los zimógenos pasen a enzimas activas, capaces de iniciar el proceso de la proteólisis.
En el caso que se trabaje con otro desinfectante, como podría ser el peróxido de hidrógeno, éste no es dependiente del pH del agua para que realice la desinfección.
Es decir, la calidad de la desinfección es igual en aguas con pH bajos o altos si se utiliza peróxido de hidrógeno.

1 2 3 4

Proteínas (en los alimentos): se descomponen en el estómago en polipéptidos (por la acción de la pepsina).
Polipéptidos: se descomponen en el intestino delgado por las enzimas proteolíticas (tripsina, quimotripsina) en péptidos más cortos.
Péptidos: se descomponen en aminoácidos libres.
Aminoácidos: son absorbidos por las células del intestino y transportados a través del sistema sanguíneo para ser utilizados por el cuerpo.

El sistema de producción de destetes precoces (21-28 días), favorece la mala absorción de las proteínas, puesto que el estómago de los lechones no está del todo desarrollado y la capacidad de producir ácido clorhídrico no es del todo suficiente como para realizar una proteólisis completa, sobre todo en dietas cada vez más hiperproteicas
Estimulación de las glándulas salivares, papilas gustativas y secreciones pancreáticas
La estimulación de las glándulas salivares favorece la producción de amilasas, como la ptialina, que inicia la digestión de los almidones en la boca. Este proceso comienza en la boca, facilitando la digestión posterior.
También tiene la función de estimular las papilas gustativas para incrementar la apetencia del agua y, por consiguiente, conseguir un incremento del consumo de alimento.
Finalmente, la adición de ácidos promueve un incremento de las secreciones pancreáticas para facilitar la descomposición más eficiente de los macronutrientes y favorecer la absorción.
2. Función prebiótica intestinal (acidificación intestinal)
Control de patógenos intestinales y reducción de trastornos digestivos
Estas malas absorciones de las proteínas, provocan fermentaciones anormales de estas en el tracto intestinal, favoreciendo las disbiosis intestinales y las diarreas.

Mediante la adición de ácidos orgánicos se busca la acidificación intestinal, ésta juega un papel muy importante en la salud digestiva de los lechones creando ambiente ácido en el intestino. De esta manera se dificulta el crecimiento de bacterias patógenas como E. coli, Salmonella y Clostridium, que son más sensibles a un pH bajo.
Esto ayuda a reducir el riesgo de infecciones intestinales y trastornos digestivos, como la diarrea post-destete, que es común en los lechones cuando se separan de la madre.

En el caso de los ácidos orgánicos, que su constante de disociación (pKa) es más alta, se mantienen más tiempo en su forma ácida en el intestino. Este ambiente ácido no solo inhibe las bacterias dañinas, sino que también favorece el crecimiento de bacterias beneficiosas, como Lactobacillus y Bifidobacterium, que son esenciales para una buena digestión y fermentación de los nutrientes.
Además, la acidez del intestino mejora la absorción de nutrientes, ya que algunos minerales y otros compuestos se asimilan mejor en un pH bajo.
En resumen, la acidificación intestinal no solo previene enfermedades, sino que también mejora la eficiencia nutricional y el bienestar general de los lechones.
La acidificación del agua es una herramienta eficaz para mejorar la salud digestiva en porcino, especialmente en momentos críticos como el destete y la fase de transición o pre-cebo (SITIO 2).

Al reducir el pH del agua, se favorece la digestión de nutrientes, se incrementa el consumo de agua y alimento, se controla la proliferación de patógenos y se promueve un microbioma intestinal saludable, lo que contribuye a un mejor rendimiento y menor mortalidad.
Implementar la acidificación del agua como parte de un manejo nutricional integral puede resultar en una mejora significativa en la salud y el bienestar de los lechones reduciendo la dependencia de antibióticos y mejorando los resultados económicos de la granja.
Tasa de crecimiento
Acidó las Bacterias Alcaló las Enterobacteria E. coli
Lactobacillus
Bi dubacterium Salmonella pH
Clostridium
0 1 2 3 4 5 6 7 8 9 10 11 12

Potencia la barrera intestinal fortaleciendo el sistema inmunológico
El agua libre de patógenos y adecuadamente acidificada favorece un microbioma intestinal equilibrado, promoviendo el crecimiento de bacterias beneficiosas que tienen un efecto positivo en la función inmunitaria.
Una microbiota intestinal saludable es clave para un sistema inmunitario eficiente, lo que permite una mejor respuesta a infecciones y otros desafíos ambientales.
La elección del acidificante es muy importante pues dependiendo de la necesidad de la explotación se recomendará el uso de unos u otros o ambos combinados.
Azix Plus es un acidificante compuesto por una mezcla de ácidos orgánicos y aditivos naturales, diseñado para establecer un ecosistema microbiano estable en el intestino de los animales. Actúa como prebiótico, formando una barrera que inhibe la proliferación de bacterias patógenas, incluyendo Salmonella, E. coli, Clostridium (entre otros).
Azix Forte es un acidificante principalmente inorgánico altamente concentrado a base de ácido ortofosfórico (70%) y ácido fórmico (10%), muy bien estabilizado, con un alto poder de acidificación y capacidad de bajar el pH del agua a muy bajas dosis.
Acidificación del agua en transición porcinaporcina: salud intestinal y producción.
DESCÁRGALO EN PDF




· Eficacia probada por normas UNE oficiales europeas.
· 100% Estable.
· 100% Biodegradable.
Servicio Técnico de Boehringer Ingelheim

El ESPHM acogió la presentación, por parte de Boehringer Ingelheim Animal Health España, de estas comunicaciones sobre el papel de la vacunación como elemento clave en la prevención de enfermedades víricas.
La mejora continua de la sanidad en producción porcina exige no solo el desarrollo de vacunas eficaces, sino también su correcta aplicación estratégica en el campo.
En este contexto, presentamos dos estudios recientes realizados en condiciones comerciales que abordan desafíos clave en el control de enfermedades víricas.

El primero analiza el impacto de la vacunación en sábana de cerdas frente a PCV-2 como herramienta para eliminar la transmisión vertical del virus.

El segundo evalúa la eficacia de la vacunación frente a una cepa altamente virulenta de PRRSv en lechones negativos trasladados a una zona de alta densidad porcina.
Ambos trabajos aportan evidencia práctica sobre cómo un enfoque preventivo y adaptado a cada situación epidemiológica puede traducirse en mejoras significativas en los parámetros sanitarios y productivos.

A. Martínez1, G. Solano2, F. Gonzalvo3* y G. Abella3,2
1Vall Companys Grup
2Pig Livestock Union
3Boehringer Ingelheim Animal Health España
*franscisco.gonzalvo@boehringer-ingelheim.com
El Circovirus Porcino tipo 2 (PCV-2) es ubicuo, estando omnipresente en la población porcina y siendo el agente esencial y principal responsable de las enfermedades (clínicas y subclínicas) asociadas a circovirosis porcina (PCVDs) (Segales J. y Sibila M., 2022).
A pesar del uso generalizado en lechones de vacunas contra PCV-2, en ocasiones aún se pueden diagnosticar casos de PCVD en animales de engorde.
Además, la falta de niveles homogéneos de inmunidad frente a PCV-2 en las cerdas puede resultar en subpoblaciones dentro del hato reproductor y en la transmisión vertical del virus (de cerdas a lechones).
Este estudio tuvo como objetivo evaluar el impacto de la vacunación de cerdas frente a PCV-2 en la reducción de la transmisión del virus a su descendencia.
El estudio se realizó en una pirámide comercial de cerdos situada en el noreste de España.
A pesar de realizar la vacunación frente a PCV-2 al destete (21 días de edad) con Ingelvac CircoFLEX® (Boehringer Ingelheim), durante la primavera de 2023 se diagnosticó PCVD en los animales de engorde basándose en:
Signos clínicos
Lesiones
Detección viral por PCR
Inmunohistoquímica
Tras la detección de circovirosis en los engordes, se estableció un programa de vacunación de las cerdas reproductoras que consistió en la inoculación de dos dosis en sábana en un intervalo de 4 semanas.
Para evaluar el impacto de esta intervención, se seleccionaron y muestrearon a los 21, 58 y 98 días de edad dos lotes de 50 lechones:

Lote 1: lechones nacidos antes de la vacunación de las cerdas.
Lote 2: lechones nacidos después de la vacunación de las cerdas.
Las muestras se analizaron mediante ELISA PCV-2 (Biochek) y qPCR PCV-2 (Real-PCR PCV2-PCV3 Multiplex DNA test), y el estudio estadístico se realizó con el software Minitab®21.

Los resultados de qPCR mostraron la presencia de PCV-2 solo en el grupo de animales previo a la vacunación de las cerdas (lote1), con cargas víricas de 8x102, 3x103 y 1x106 a los 21, 58 y 98 días de edad, respectivamente (Gráficas 1 y 2).
En los lechones nacidos de las cerdas vacunadas (lote 2) los análisis serológicos indicaron un incremento de los anticuerpos maternales a los 21 días (1,36a vs 1,2b) y, a pesar de ello, una buena respuesta a la vacunación a los 58 días (0,8a vs 1,1b) y a los 98 días (1,5ª vs 0,8b).
Estas diferencias en respuesta serológica fueron estadísticamente significativas en todos los puntos de muestreo entre los grupos de animales antes y después de la vacunación de las cerdas (Gráfica 3).

Antes del establecimiento de un programa de vacunación en cerdas frente a PCV-2, la respuesta de anticuerpos era variable, heterogénea y errática, correspondiendo más a una circulación incontrolada del virus que a una correcta respuesta vacunal. En ese escenario se detectó PCV-2 en todos los puntos de muestreo.

Tras aplicar el protocolo de vacunación en cerdas con Ingelvac CircoFLEX®, la transmisión vertical del virus desapareció por completo ya que no se detectó viremia de PCV-2 en ninguna de las muestras de suero y, tras el declive de la inmunidad materna, se observó una buena respuesta a la vacunación hasta los 98 días.
21 días 58 días 98 días
Gráfica 1. Resultados de qPCR del PCV-2 lote 1 (lechones antes de la vacunación de cerdas).
21 días 58 días 98 días
Gráfica 2. Resultados de qPCR PCV-2 del lote 2 (lechones después de la vacunación de cerdas).

Lote 1. Cerdas NO vacunadas
Lote 2. Cerdas vacunadas
Gráfica 3. Respuesta serológica de los lechones a 21, 58 y 98 días postvacunación. Lote 1: antes de la vacunación de las cerdas. Lote 2: lechones de cerdas vacunadas. Las letras (a, b) indican diferencias estadísticamente significativas entre grupos en cada punto de muestreo (p < 0,05).
Este estudio demostró que la doble vacunación de cerdas con Ingelvac CircoFLEX®:
Reduce la transmisión vertical de PCV-2 de cerdas a lechones.
Proporciona una inmunidad maternal más elevada y homogénea.
La respuesta a la vacunación de los lechones a los 21 días de edad fue óptima tras detener la transmisión vertical de PCV-2, a pesar del aumento de la inmunidad maternal inducida por las vacunaciones en sábana de las madres (Figueras S. et al., 2019).
V. Benedicto1, C. Muñecas1, T. Coll2 y S.Figueras2
1Pormascop
2Boehringer Ingelheim Animal Health España
La enfermedad causada por el virus del Síndrome Reproductivo y Respiratorio Porcino (PRRSv) ocasiona graves pérdidas en la producción porcina española que se han visto acentuadas en los últimos años tras la introducción de cepas altamente virulentas, como Rosalía (Martín-Valls GE et al., 2023).

El PRRS es especialmente preocupante para las empresas que producen lechones negativos que son trasladados a áreas de alta densidad para ser engordados.
El objetivo de este estudio fue medir el impacto de la vacunación frente al PRRSv sobre los resultados productivos de lechones producidos en una granja de madres negativa a PRRSv, que son engordados en un cebadero situado en una zona de alta densidad porcina con circulación frecuente del virus.

El estudio se llevó a cabo en un engorde situado en una zona de alta densidad de Teruel (Imagen 1).
Los animales entraron con una semana de diferencia y un peso alrededor de 12 kg, alojándose en dos naves idénticas de 1.230 animales cada una, separadas por los vestuarios.
Grupo NOVAC: lechones sin vacunar y alojados en la nave 2.
Grupo VAC: lechones vacunados a la entrada con 1 dosis de 1 ml (vía intramuscular) de Ingelvac PRRSFLEX® EU (Boehringer Ingelheim Vetmedica GmbH) y alojados en la nave 1.
Se tomaron muestras de sangre de 30 animales de cada grupo para hacer PCR y ELISA en suero antes de la vacunación, al inicio de la clínica y a los 15 y 30 días después del inicio de los síntomas.
Los datos de producción de los animales se registraron individualmente por nave durante todo el engorde.
Las estadísticas se realizaron con Minitab®20.2 y se utilizó la herramienta Becal (Becal ROI calculator) para calcular el retorno de la inversión (ROI) de la vacunación.

Imagen 1. Vista aérea del cebadero donde se desarrolló el estudio, ubicado en una zona de alta densidad porcina en Teruel.

Grupo VAC (Nave 1)
Ingelvac PRRSFLEX EU
Grupo NOVAC (Nave 2) No vacunados Vestuarios
Imagen 2. Distribución de los grupos experimentales en el cebadero. Los lechones vacunados con Ingelvac PRRSFLEX® EU (grupo VAC) se alojaron en la nave 1, mientras que los no vacunados (grupo NOVAC) se ubicaron en la nave 2. Ambas naves, de diseño idéntico y capacidad para 1.230 animales, estaban separadas por los vestuarios, lo que permitió mantener condiciones independientes durante todo el periodo de engorde.

Todos los animales muestreados fueron negativos la entrada en las naves de engorde.
A las 6 semanas comenzaron los síntomas clínicos en la nave 2, observándose apatía, fiebre y anorexia en los animales no vacunados.
Se tomaron muestras de sangre obteniéndose PCR + (Gráfica 4), determinándose mediante secuenciación que era una variante de la cepa Rosalía.
Los cerdos de la nave 1, que fueron vacunados, permanecieron negativos hasta dos semanas más que los no vacunados, siendo la viremia menor en todos los muestreos, tanto en carga vírica como en duración total (Gráfica 4).
Gráfica 4. Evolución del porcentaje de animales PCR positivos y valores Ct en los grupos vacunado (nave 1) y no vacunado (nave 2). Se observa una detección más temprana, más intensa y prolongada de viremia en los animales no vacunados (grupo NOVAC), mientras que los vacunados (grupo VAC) mostraron una menor proporción de positivos y valores Ct más elevados, indicativos de menor carga vírica.
Al final del engorde se observaron las siguientes diferencias en los resultados productivos en el grupo de animales vacunados (grupo VAC):
13 % menos de mortalidad (p<0,001) (Gráfica 5)
8 días menos de estancia en cebadero
40 g más de Ganancia Media Diaria (GMD)
298 g menos de Índice de Conversión (IC)

Gráfica 5. Mortalidad absoluta y porcentaje acumulado de mortalidad en los grupos vacunado (VAC) y no vacunado (NO VAC) durante el periodo de engorde. Se observa una diferencia marcada a partir de mediados de febrero, con una mortalidad

Bajo las condiciones de este estudio, observamos una gran diferencia en los parámetros productivos de ambos grupos, destacando que en el grupo vacunado la mortalidad que fue 3 veces menor y la conversión que fue inferior en 298 g, lo que supone un ROI estimado de 30:1.
La salida de los cerdos vacunados al matadero fue 8 días antes, habiendo entrado en el cebo 7 días después.
Este estudio demuestra la utilidad de la vacunación con Ingelvac PRRSFLEX® EU como herramienta para evitar las pérdidas económicas de cepas de PRRSv altamente virulentas, como Rosalía, cuando por razones logísticas tenemos que trasladar animales negativos a zonas de alta densidad.
Los resultados de ambos estudios confirman que la vacunación estratégica, adaptada al contexto sanitario de la granja, es una herramienta clave para prevenir la transmisión vertical de PCV-2 y mitigar el impacto productivo del PRRSv.
Implementar programas vacunales bien diseñados no solo mejora la salud de los animales, sino que también se traduce en beneficios económicos claros para las explotaciones.

Becal ROI calculator. https://www.preventionworks. info/



Cada reto es una oportunidad de éxito
Evita las soluciones a corto plazo y mejora tu productividad.
Con más de 30 años de experiencia en el sector porcino hemos desarrollado vacunas, servicios y herramientas tecnológicas eficientes que harán tu negocio sostenible en el tiempo.

María J. Vilar1, Cristiana Teixeira Justo1 y Cristina Muñoz Madero2 1Técnico científico del PRAN en Sanidad Animal 2Coordinadora del PRAN en Sanidad Animal
La resistencia a los antimicrobianos (RAM) es una de las mayores amenazas para la salud pública a nivel global.
En España, la piedra angular para abordar este problema es el Plan Nacional frente a la Resistencia a los Antibióticos (PRAN), alineado con las estrategias de la Unión Europea (UE) y del cuatripartito (la Organización de las Naciones Unidas para la Alimentación y la Agricultura (FAO), la Organización Mundial de Sanidad Animal (OMSA), la Organización Mundial de la Salud (OMS) y el Programa de las Naciones Unidas para el Medio Ambiente (PNUMA)).


Salud humana

Desde sus inicios en 2014, el PRAN ha asentado las bases del abordaje de la resistencia antimicrobiana mediante una estrategia One Health que integra la salud humana, la sanidad animal y el medioambiente.
Sanidad animal
ONE HEALTH
Medioambiente
Son ya cuatro los planes adoptados desde entonces y cada uno de ellos ha supuesto un avance tangible, evidenciado en la reducción progresiva del consumo de antibióticos que ha llevado a España a posicionarse como un referente en la lucha contra esta amenaza global.

Este año se ha puesto en marcha el PRAN 2025-2027, que da continuidad al trabajo realizado hasta el momento, consolidando los proyectos existentes, extrapolándolos a otras áreas e impulsando nuevas acciones que responden a otros retos emergentes.
ACCEDER AL PRAN 2025 – 2027
En sanidad animal en concreto, este nuevo plan tiene previsto:
El desarrollo e implementación de los Programas de Optimización del Uso de Antimicrobianos (PROA), tanto para animales de producción como para animales de compañía.
La creación de un grupo de trabajo para mejorar el control y prevención de las infecciones (CPI), en línea con la Acción Conjunta Europea contra las Resistencias Antimicrobianas y las Infecciones asociadas a la Atención Sanitaria (EU-JAMRAI2).
La consolidación de la Red de Vigilancia Europea de Ventas y Uso de Antimicrobianos en Veterinaria (ESUAvet).
El desarrollo y consolidación del proyecto de Vigilancia de Bacterias Patógenas Clínicas y de resistencias en animales silvestres.
Mejorar la disponibilidad a medicamentos veterinarios con antimicrobianos o con alternativas a los mismos.
Apostar por la formación y la sensibilización de todos los implicados en el uso prudente de antimicrobianos.

El PRAN ha dado un paso más con el desarrollo de los Equipos PROA en sanidad animal.
Estos programas se centran en la prevención de las enfermedades infecciosas de cara a la reducción de uso de antimicrobianos, destacando la prevención y control de la aparición y difusión de RAM, además de garantizar el acceso sostenible a tratamientos eficaces.
Son de aplicación, tanto en animales de producción como en animales de compañía.

Para el desarrollo e implementación de estos programas se requiere de la participación de diferentes actores con una definición clara de sus responsabilidades y de las medidas o intervenciones a implementar.
Entre estas intervenciones se encuentran:
La monitorización y vigilancia de las RAM y del consumo de antimicrobianos.
Las medidas de CPI en los animales.
El uso adecuado de antimicrobianos.
La disponibilidad de una amplia gama de medicamentos antimicrobianos eficaces y de alternativas a los mismos como vacunas u otras terapias de prevención o tratamiento.
La formación y sensibilización en la materia de los veterinarios, ganaderos y dueños de los animales.
El marco regulatorio aplicable.
Estas iniciativas incluyen:
La identificación de los actores necesarios en cada área.
El establecimiento de indicadores que permitan evaluar el grado de implementación de los PROA.
La elaboración de una formación y/o sensibilización a los actores.
La integración de la información recogida en los sistemas de vigilancia. El objetivo es claro: reducir el uso innecesario de antimicrobianos, prevenir resistencias y mejorar la sanidad y el bienestar animal dentro de un enfoque One Health que aúna salud humana, animal y ambiental.



Las acciones para 2025-2027 en el sector porcino, de manera general, incluyen apoyar y asesorar al sector en la implementación de los PROA, para lo cual se usarán como referencia las guías estándar PROA que se están elaborando a nivel europeo.
En ellas se identificarán:
1
2
Los actores necesarios (p.ej. ganaderos, veterinarios y otros profesionales relacionados, expertos científicos, etc.).
Los elementos y/o intervenciones necesarias (p.ej. prácticas de bioseguridad, CPI, monitorización y vigilancia de uso de antibióticos y resistencia, etc.).
3
Se incluirán indicadores que permitan evaluar el grado de implementación de los mismos.
La información recogida en el primer informe ESUAvet sirve además como punto de referencia para promover el uso óptimo de antimicrobianos.
ACCEDER AL PRIMER INFORME ESUAvet
Los datos muestran el compromiso del sector con la protección de la salud pública y animal.
El informe refleja que la mayor parte de los antimicrobianos utilizados en porcino (66 %) pertenecen a la categoría AMEG D “uso con prudencia”, lo que muestra el compromiso del sector porcino con la protección de la sanidad y bienestar animal, además de la salud pública, al ser considerados de menor impacto en la RAM.
Dicho informe muestra que queda margen de mejora, al mostrar que el consumo de antibióticos de categoría C “uso con cautela “es relativamente alto (32%).


Para favorecer la comunicación multidireccional, se organizarán reuniones de seguimiento de manera periódica con el grupo de trabajo del sector porcino establecido en el marco del PRAN.
En estas reuniones se elaborarán planes de actuación, por ejemplo, identificando las enfermedades infecciosas con mayor impacto en el consumo de antimicrobianos que son prevenibles con intervenciones como la implementación de medidas de CPI y de bioseguridad.
Se podrá crear también un banco con recomendaciones de buenas prácticas al sector.
Otra de las acciones planificadas es diseñar una formación y/o sensibilización de los actores sesiones formativas específicas a
En definitiva, el PRAN 2025-2027 representa un avance decisivo en la mejora de la sanidad animal, promoviendo un uso responsable y sostenible de los antimicrobianos.
Este plan estratégico no solo fortalece las medidas de prevención y control de enfermedades, sino que también contribuye a salvaguardar la salud pública y el medioambiente.
Su éxito dependerá del compromiso y la colaboración estrecha entre todas las partes implicadas, consolidando así un sector ganadero más seguro y sostenible para el futuro.
Plan Nacional frente a la Resistencia a los Antibióticos (PRAN) 2025-2027: Una estrategia integral para preservar la salud pública, animal y ambiental DESCÁRGALO EN PDF





Javier Abadías, Clara Farré, Jonás Hernández y Ester Maiques
Servicio Técnico Porcino ZOETIS
La convivencia con cepas hipervirulentas del virus del Síndrome Respiratorio y Reproductivo Porcino genotipo 1 (PRRSv) provoca grandes desequilibrios sanitarios en las granjas, con pérdidas no solo reproductivas si no también por su impacto respiratorio.

Tanto veterinarios como ganaderos ven cómo la incidencia en pérdidas reproductivas en el brote inicial por PRRSv cepa Rosalía parecen imparables, lo que provoca inseguridad y desconfianza en los protocolos sanitarios y de bioseguridad de la granja.
El objetivo de este artículo es explicar cómo la vacunación con una vacuna viva atenuada puede ser una herramienta útil frente al brote, reduciendo el impacto inicial y después alcanzando la recuperación de la estabilidad en cerdas y lechones.

El objetivo de vacunar a las cerdas es aumentar la supervivencia de sus lechones y, para ello, es fundamental estimular una inmunidad consistente en ellas. Esta inmunidad tiene una doble función:
Mantener la gestación evitando un aborto o un parto temprano a los lechones
La vacunación ha demostrado lograr una reducción de la infección transplacentaria causada por el virus PRRS durante el último tercio de la gestación, reduciendo la incidencia de mortinatos y la viremia en los lechones al nacimiento.
Precauciones adicionales a la vacunación de cerdas y reposición
La reposición con nulíparas negativas en las granjas es importante para evitar la entrada de nuevas cepas en la granja, pero estos animales deben inmunizarse antes de entrar en contacto con el resto de cerdas adultas positivas a PRRSv.
La recomendación es vacunar la reposición antes de la primera inseminación en la unidad de cuarentena y antes de que se expongan a una cepa de campo.
Si se introduce en gestación a una reposición que nunca ha sido expuesta previamente al virus PRRS, se debe evitar su vacunación con PRRS vivo atenuado en la segunda mitad de gestación ante el riesgo de alteraciones reproductivas.


La ingestión de calostro de la madre será fundamental para la transferencia inmunitaria humoral al lechón y, además, lo prepara para el desarrollo de la inmunidad celular.
La monitorización de la situación sanitaria en las cerdas se hace muy práctica con el diagnóstico sobre fluidos de procesado y lenguas de nacidos muertos mediante PCR PRRS.
Es recomendable hacer diferentes pools o grupos de muestras, separándolas en función de la paridad, sobre todo con los lechones de primer y segundo parto.
El diagnóstico por PCR PRRS DIVA permite determinar si:
Está la cepa de campo.
Solo está la cepa vacunal debido a una vacunación reciente en cerdas.
Coexisten ambas cepas.

La duración de inmunidad alcanzar los 6 meses en reproductoras, debiendo ajustarse el protocolo vacunal según:
La situación sanitaria de la granja.
La presión de infección alrededor de la granja.
La opinión del veterinario.
¿Es importante vacunar los lechones tras un brote por Rosalía?


Sí. Dado que la excreción oronasal es la principal vía de diseminación del virus PRRS, la vacuna debe reducir la cantidad de virus excretado, rápida y significativamente, a los pocos días del desafío con la cepa de campo.
Si es tan importante, ¿con qué edad estarán protegidos los lechones por inmunidad vacunal?
El objetivo es reducir el período de riesgo en el que la inmunidad maternal ya no es eficaz y la inmunidad vacunal aún no se ha desarrollado.
Dependerá de dos factores:
Establecimiento de la inmunidad
Es importante que la inmunidad vacunal se establezca antes de la infección por PRRSv, lo que ocurre normalmente a las 3 semanas después de vacunar los lechones.
Esto se demuestra en animales sanos y es una razón por la que no se aconseja vacunar animales enfermos.
Es importante tener en cuenta cuándo se puede empezar la vacunación, ya que la mayoría de las vacunas están limitadas en el momento de la vacunación por la interferencia de la inmunidad maternal.
Existe la posibilidad de vacunar desde el primer día de vida , siendo en el procesamiento el momento escogido normalmente en las granjas para su aplicación. Para ello, la vacuna debe superar la interferencia de los anticuerpos maternales, alcanzar los macrófagos alveolares porcinos y multiplicarse en ellos rápidamente.
Una prueba de que la instauración de la inmunidad va por buen camino, está en si podemos detectar la cepa vacunal en los lechones con pocas semanas de vida.
Los animales, tras la vacunación intramuscular con cepas vivas atenuadas, pueden excretar la cepa vacunal más de 16 semanas y, en caso de vacunación intranasal, este período es de más de 10 semanas.


¿Cuál es el momento de establecer el protocolo vacunal en los lechones, tanto el principio como el final de la vacunación?
Existe un período de tiempo en el que hay una posible convivencia de la cepa vacunal con la cepa de campo en la granja y el objetivo será que solo se mantenga la cepa vacunal.
El principio del período de vacunación está definido por los primeros lechones nacidos no virémicos al PRRSv de campo, siendo importante diferenciarlo de la cepa vacunal en el momento del diagnóstico en caso de vacunación de cerdas.

Es de gran ayuda tener en cuenta el aspecto general y la viabilidad de los lechones al nacimiento para la tomar la decisión de iniciar la vacunación.
Al principio del brote aparecen gran número de lechones virémicos y existe riesgo de recombinación entre cepas de campo y vacunal PRRSv.
Esta es la segunda razón por la que está desaconsejada la vacunación de lechones enfermos.
El final del período de vacunación estará definido por el desplazamiento de la cepa de campo.
Este período es variable, dependiendo de:
La cepa de PRRSv que se trate.
Las medidas de manejo complementarias a la vacunación.
La bioseguridad en la granja.
Habrá granjas que, debido a estos factores, tienen recomendado mantener la vacunación de lechones incluso cuando no se encuentra la cepa de campo por su elevada probabilidad de rebrote.
El diagnóstico es una herramienta crucial y la PCR PRRS DIVA permite diferenciar entre ambas cepas monitorizando los progresos en el control de la enfermedad.



Para limitar el riesgo potencial de recombinación entre las cepas vacunales del virus PRRS del mismo genotipo, se recomienda no usar diferentes vacunas vivas atenuadas basadas en diferentes cepas del mismo genotipo en la misma granja y al mismo tiempo, por ejemplo, una vacuna en cerdas y otra vacuna en lechones.



Las dosis de vacuna reconstituidas y almacenadas en granjas pueden perder actividad de un uso para otro. Por ello, es muy importante conservar y transportar la vacuna refrigerada (2-8 °C), sin congelar y protegido de la luz.























En caso de transición de una vacuna viva atenuada frente al PRRS a otra vacuna viva atenuada frente al PRRS, deberá respetarse un periodo de transición entre la última administración de la vacuna actual y la primera administración de la nueva vacuna.
El periodo de transición deberá ser más largo que el periodo de excreción de la vacuna actual tras la vacunación, no debiendo rotar rutinariamente dos o más vacunas comerciales vivas atenuadas de distintas cepas frente al virus PRRS en una explotación

El control de un brote de PRRS requiere un conjunto de medidas en las que todas se deben clasificar como importantes y la vacunación demuestra ser una de ellas.
El uso de una vacuna de PRRSv debe ajustarse a las características de la granja para un manejo correcto de las expectativas en los progresos sanitarios.
Así, tanto la vacunación de cerdas como de lechones aportarán beneficios.
Proteger frente al virus PRRSCepa Rosalia DESCÁRGALO EN PDF



• La protección más temprana incluso antes del período de riesgo en el destete
• Vacuna con línea celular única, autorizada para su uso en lechones desde el primer día de vida, animales de reposición y cerdas
• Protección de larga duración durante la fase de cebo


Para alcanzar el máximo rendimiento en las granjas porcinas, no solo es necesario contar con una buena genética, un adecuado manejo en los sistemas de producción, alimentación, reproducción, medidas sanitarias y de bioseguridad, también es importante contar con un excelente control ambiental.
Lograr un equilibrio adecuado de temperatura, humedad y ventilación es esencial para la salud de los cerdos, su crecimiento óptimo, rentabilidad y sostenibilidad de las granjas.
Según el Código Terrestre de la Organización Mundial de Sanidad Animal (OMSA) el Bienestar Animal se define como “el estado físico y mental de un animal en relación con las condiciones en las que vive y muere”.
Libre de hambre, sed y desnutrición
Libre de molestias físicas y térmicas

Libre de temor y angustia
CINCO LIBERTADES
Libre de dolor, lesiones y enfermedades
Libre para manifestar un comportamiento natural
Este artículo se centra en el manejo de la ventilación para maximizar el bienestar animal.
El objetivo de un sistema de ventilación es de efectuar los cambios de aire necesarios para el mantenimiento adecuado de la humedad y la temperatura ambientales dentro de limites aceptables.
Las normas establecidas en la producción porcina son pautas aproximadas y dependen, entre otros, de:
El sistema de ventilación utilizado
La edad y comportamiento de los animales
El estado de salud de los animales
La ingesta de alimento
Los estándares de ventilación mínima se basan en una concentración máxima de CO2 de 3.000 ppm, siempre medida mientras los animales están descansando (Tabla 1).
Valores aproximados, convertidos de tasa de flujo de aire en cfm a m³/h usando el factor 1 cfm ≈ 1,7 m³/h
Tabla 1. Tasas de ventilación recomendadas para las diferentes etapas de producción porcina.
Movimiento y calidad de aire
El edificio y el sistema de ventilación deben estar diseñados de tal manera que el aire no se mueva al nivel de los animales para evitar molestas corrientes de aire.
El movimiento inadecuado provoca una mala calidad del aire, lo que afecta negativamente a la salud de los cerdos y de los trabajadores de la granja.
Una ventilación adecuada ayuda a minimizar los gases, el polvo y a controlar la humedad del edificio.
Los gases más importantes que se deben monitorizar en las instalaciones porcinas son:
Amoníaco (NH3 )
Sulfuro de hidrógeno (H2 S)
Dióxido de carbono (CO2)
Metano (CH4)
aVLU (Valor Límite Umbral) designa las condiciones bajo las cuáles se considera que el personal puede ser expuesto durante una jornada de 8 horas diarias y 40 horas por semana sin que haya efectos adversos.
bFactor de difusión: designa la magnitud de difusión con respecto al VLU.
cLímite de la MTO (Media del Tiempo Ponderado) designa la concentración máxima permitida para un periodo corto de exposición. VLU x Factor de difusión = límite de MTP
Tabla 2. Normas de seguridad para los gases dentro de las naves de producción porcina.
Para asegurar que estas normas se respetan se utilizan diferentes herramientas, como los tubos de tracción (Imagen 1) que miden el NH3 en el ambiente, debiendo permanecer este en niveles por debajo de 25 ppm.
Las causas más comunes de los altos niveles de NH3 además de la ventilación insuficiente, son los suelos sucios y el mal manejo de los excrementos y orina en las fosas de almacenamiento.
ACCEDE A LAS DIRECTRICES DEL CCAC SOBRE EL CUIDADO DE LOS CERDOS

Imagen 1. Ejemplos de tubo de tracción con bomba para la medición de concentración de amoniaco.
La primera consideración es usar controles para regular la temperatura de manera efectiva.
Los cerdos son muy sensibles a las fluctuaciones de temperatura y, por tanto, mantener una temperatura adecuada dentro de las naves es crucial.

El control de la humedad es otro aspecto vital de la gestión del clima en las granjas porcinas.
Los niveles altos de humedad pueden provocar molestias en los animales y crear un ambiente propicio para el crecimiento de microorganismos nocivos.
Los niveles bajos de humedad pueden causar problemas respiratorios.
Imagen 2. Monitorización y medición de la temperatura corporal de los cerdos mediante imágenes IRT (Fuente: Reza MN, 2024).
(a) Monitorización de la temperatura del canal auditivo y el canto ocular, (b) áreas corporales infectadas expuestas, (c) cambios en el monitoreo de la temperatura utilizando diferentes ángulos de cámara y densidades de cerdos, (d) efecto en la variación de temperatura para el cuerpo del lechón y el área rectal, y (e) monitoreo de la temperatura del cuerpo del cerdo durante la actividad regular.


Ventilación natural
Depende del viento y de la variación de la temperatura exterior, por lo que es difícil mantener las temperaturas recomendadas equilibradas para cada etapa de producción.
Generalmente, la ventilación natural se utiliza más en los cerdos en la fase de crecimiento (≥30 kg), ya que estos pueden retener más calor y controlar su temperatura corporal.
Ventilación forzada
Es la forma más popular de uniformar adecuadamente la temperatura y, hasta la fecha, la más avanzada tecnológicamente, pudiendo ser:
Negativa sin y con filtración
Positiva, sin y con filtración
Los edificios con ventilación mecánica suelen recomendarse para las maternidades y en la etapa de destete (≤6-30 kg) ya que su diseño permite controlar la temperatura dentro de los edificios durante todo el año.
dentro / Todo
Para las cerdas recién paridas, los lechones recién destetados y los cerdos recién movidos al área de crecimiento, se recomienda que la temperatura sea 1-2 °C superior a los valores de la tabla durante los dos primeros días. Cuando los cerdos cambian de alojamiento (es decir, recién nacidos, destetados o recién llegados a la engorda), están sujetos al estrés de adaptarse a su nuevo entorno y dieta. El estrés generalmente causará una reducción en la ingesta de alimento y, por lo tanto, una reducción en el calor corporal interno. Por lo tanto, es deseable una temperatura ambiente más cálida. También, el aumento de la temperatura de la temporada de calor hasta la temporada a la de frío debe ir acompañado de un ajuste mínimo de la ventilación.
Tabla 3. Temperaturas recomendadas por etapa y peso (Fuente: Pork Production Reference Guide, Prairie Swine Centre).
El bienestar de los cerdos debe ser evaluado mediante un sistema integrado basado en:

1Herramientas para medir adecuadamente los factores mencionados anteriormente y las nuevas tecnologías disponibles.
Los cerdos hablan, aprendamos a escucharlos (Figura 4).
Temperatura Crítica Mínima (TCM)
Frío
Amontonamiento
Menor contacto con el piso
Temperatura corporal inestable ≤39 oC
Aumento en el consumo de alimento
Escalofrío / Temblor
KPI (indicadores claves de producción) que se dividen en cuatro categorías:
Rendimiento productivo y reproductivo
Clínica observada en cada granja y/o área de producción
Respuesta al programa de vacunación y/o medicación
Comportamiento de los animales
AUMENTO DE TEMPERATURA Muerte
Zona de confort termoneutral
Confortable
Temperatura Crítica Evaporativa (TCE)
Contacto normal con otros cerdos
Temperatura corporal normal 39 oC
Consumo de alimento normal
Conducta normal
20 - 30 respiraciones por minuto = 60-80
Temperatura Crítica Máxima (TCMax)
Calor
Animales dispersos
Aumento del contacto del piso
Aumento de la temperatura corporal
Disminución en el consumo de agua y alimento
Aumento en conducta anormal, corrales sucios y húmedos
Aumento en las respiraciones por minuto = 60-80
Sobrecalentamiento
Aumento en la temperatura corporal > 43 oC
Posibilidad de mortalidad
Imagen 4. La respuesta de los cerdos a los cambios de temperatura (Adaptado de Kuger et al. 1992. Australian Pig Housing Cooling Series, New South Wales Agriculture, Tamworth Australia).

El control ambiental adecuado en las granjas porcinas requiere de una comprensión integral de las necesidades específicas de los animales y las instalaciones de cada granja.
El manejo efectivo de la ventilación permite mantener la salud y la productividad de los cerdos, junto con un ambiente óptimo para los trabajadores de la granja.
Hoy en día, el factor más importante para asegurar el cuidado apropiado de los animales domésticos es capacitar y concienciar al personal sobre qué es el Bienestar Animal, así como de la importancia de su propio bienestar.
Trabajar en la sostenibilidad se basa en el principio de asegurar las necesidades del presente sin comprometer las necesidades de las generaciones futuras y sin renunciar a la protección del medioambiente, el crecimiento económico y el desarrollo social.
¡Sigamos mostrando al mundo nuestro compromiso con el futuro!
Ventilación en granjas porcinas: clave para el bienestar y la productividad DESCÁRGALO EN PDF


Lechones de alta calidad: peso y homogeneidad al nacimiento

GRASA DORSAL < 6.3mm
Unos machos elegidos para sus calidades de canal y su rendimiento para todas las oportunidades
Descendientes con alto potencial de crecimiento y de IC
Calidad de canal con buena clasificación al matadero
GMD > 1 100 Un excelente crecimiento
IC < 2.09
Un macho rentable con uno de los costes alimenticios más bajos del mercado
María Rodríguez1, Joaquín Morales1, Gonzalo Díaz-Amor1, Antonio González-Bulnes2, Hamadi Karembe3 y Daniel Šperling3
1 PigCHAMP Pro Europa S.L.
2 Universidad Cardenal Herrera-CEU
3 Ceva Santé Animale
Resumen del artículo “Influence of the application methods of iron/anticoccidial products on the behaviour and associated stress factors of suckling piglets” publicado por María Rodríguez, Joaquín Morales, Gonzalo Díaz-Amor, Antonio González-Bulnes, Hamadi Karembe y Daniel Sperling en Acta Vet. Brno 2022, 91: 251-259.
En la producción porcina, las primeras semanas de vida del lechón son determinantes para su salud, crecimiento y supervivencia.
Durante este periodo, la prevención de patologías como la anemia ferropénica y la coccidiosis resulta esencial, al igual que el manejo adecuado para minimizar el estrés y preservar el Bienestar Animal.
En este contexto, diferentes estrategias terapéuticas buscan no solo garantizar la eficacia sanitaria, sino también reducir la carga de manipulaciones que los animales deben afrontar.



Este estudio comparó el efecto de Forceris® con el de una inyección de hierro y aplicación oral de toltrazurilo sobre el comportamiento y el reparto del tiempo de los lechones.
Forceris® combina la administración de hierro y toltrazurilo en una sola inyección, lo que:
Reduce el número de manipulaciones de los lechones.
Puede disminuir su estrés y el impacto negativo sobre su comportamiento y bienestar.
Este estudio compara el efecto de un tratamiento combinado parenteral contra la anemia ferropénica y la coccidiosis con el de la inyección intramuscular de hierro y la aplicación oral de toltrazurilo.
En el estudio se emplearon 36 lechones macho y 36 lechones hembra de madres híbridas (3er a 5º parto) y con el mismo tamaño de camada.
Los lechones tenían tres días de vida (48 - 72 h) al inicio del estudio (peso vivo inicial: 1,5 - 2,0 kg) y 21 días (peso vivo final: 5,0 - 6,0 kg) a su conclusión.

Las cámaras de vídeo grabaron la actividad de los lechones 3 horas antes (-3 h, -2 h y -1 h) y 3 horas después (+1 h, +2 h y +3 h) del tratamiento.
Las imágenes fueron analizadas por dos observadores con el software VLC y se muestreó cada 3 min el comportamiento de los lechones:
En las primeras 24 h después del nacimiento, los lechones se identificaron individualmente con crotales y se pesaron, distribuyéndose en tres grupos de tratamiento experimental:
Grupo Control (C): 24 lechones no recibieron tratamiento (sin tratamiento con hierro/ agentes anticoccidiósicos, sin manipulación).
Grupo Oral + Parenteral (O+P): 24 lechones recibieron una administración oral de un agente anticoccidiósico genérico (20 mg/kg de peso vivo), más la administración intramuscular de hierro dextrano (200 mg/ml; 1 ml/lechón) en el mismo manejo.
Grupo Parenteral (P): 24 lechones recibieron una única aplicación intramuscular de producto combinado (1,5 ml).
Activo: amamantamiento + interacciones positivas + locomoción normal + exploración.
Neutro: reposo + sentarse + estar de pie.
Con el fin de evaluar el nivel de estrés de los lechones, se midió la concentración de cortisol en suero mediante un kit ELISA comercial.
El grupo O+P tuvo un tiempo de manejo superior (198,5 ± 22,98 s) en comparación con el grupo P (111,5 ± 22,98 s) pero no fue significativo (p > 0,05). Los lechones del grupo C no se manipularon.
En los valores de las 3 horas anteriores a la administración del tratamiento no hubo diferencias en ninguna de las conductas estudiadas (p > 0,05).
Los animales de los tres grupos presentaron un comportamiento neutro la mayor parte del tiempo (70,2 % ± 8,97 %), básicamente descansando (64,2 % ± 8,11 %). En cuanto al comportamiento activo (26,0 % ± 8,95 %), era mayormente amamantamiento (17,3 % ± 9,30 %).
Después del tratamiento, las interacciones positivas fueron mayores (p = 0,06) inmediatamente después (+1 h) debido a la manipulación de los lechones.
Los principales comportamientos activos y neutros fueron amamantamiento y descanso, respectivamente.
Se observa que las variaciones en el comportamiento de los lechones C están en la línea del comportamiento normal. En cambio, en los animales tratados se observaron diferencias:
Tras el tratamiento (+1 h), los lechones de los grupos O+P y P pasaron más tiempo mamando, siendo el incremento prácticamente igual para ambos grupos.
A las dos horas (+2 h), los lechones O+P disminuyeron el tiempo de lactación y los del Grupo P lo aumentaron más de un 20 %.
A las tres horas (+3 h), el grupo O+P volvió a aumentar el tiempo de lactación, aunque no alcanzaron los valores de los lechones P. En general, los lechones P pasaron más tiempo mamando durante estas 3 horas postratamiento.
Porcentaje de tiempo dedicado al amamantamiento
Tiempo postratamiento
+1h +2h +3h

En la Gráfica 2 se muestra la variación del porcentaje de tiempo que los lechones dedicaron a descansar a las 1, 2 y 3 horas tras la administración del tratamiento, tomando como valor de referencia el porcentaje de tiempo de reposo 3 h antes del tratamiento.
Las fluctuaciones que se observaron en el amamantamiento también se encontraron en el comportamiento de reposo para los grupos C y O+P. La variación del tiempo de reposo en el grupo P fue menor.
Porcentaje de tiempo dedicado al reposo (%)

Tiempo postratamiento
En cambio, se observó una tendencia estadística de menor concentración de cortisol en el día 0 para el grupo P en comparación con O+P (p = 0,08) con un valor medio de 4,9 µg/dl (± 1,557) frente a 6,78 (± 2,46), respectivamente (Gráfica 3).
Gráfica 2. Variación del porcentaje de tiempo (%) dedicado al reposo a la hora (+1 h), dos (+2 h) y tres (+3 h) horas tras la administración del tratamiento (derecha), teniendo como valor de referencia el porcentaje de tiempo dedicado a cada comportamiento 3 h antes de la administración del tratamiento, observado en los grupos control negativo (C), oral + parenteral (O+P) y parenteral (P).
rendimiento del crecimiento de los lechones se muestra en la Tabla 1.
Los animales tenían pesos vivos similares al comienzo del ensayo (p > 0,05).
La GMD durante la lactación fue mayor en lechones del grupo P (similar a C) en comparación con el grupo O+P (p < 0,01). Como consecuencia, el peso vivo de los lechones al destete también fue mayor en los grupos C y P en comparación con el grupo O+P (p < 0,01).
Peso vivo al nacimiento (kg)
Peso vivo al destete (kg)
Gráfica 3. Distribución de los niveles de concentración basal de cortisol observados en el día 0 para el grupo parenteral (P) en comparación con los grupos oral + parenteral (O+P) y control (C).
a,bValores en la misma fila sin superíndice común son significativamente diferentes (p = 0,05). GMD: Ganancia Media Diaria
Tabla 1. Peso vivo al nacimiento y al destete y ganancia media diaria durante el período de lactación (28 días) de lechones de diferentes grupos experimentales: control negativo, oral + parenteral y grupo parenteral.

Aunque las diferencias no fueron significativas debido al bajo número de lechones utilizados, la inyección con producto combinado redujo el tiempo de manipulación en comparación con la administración por separado.
La manipulación de los lechones es un factor estresante con efectos negativos que persisten después de que los lechones sean devueltos a su corral.
El porcentaje de tiempo dedicado a cada comportamiento fue similar antes de la administración del tratamiento y en concordancia con la literatura previa.
Tras el tratamiento hubo cambios:
Lechones O+P: el toltrazurilo es conocido por su sabor amargo, lo que podría explicar la alteración del comportamiento de los lechones del grupo O+P que, sin diferencias significativas, mostraron un mayor comportamiento de exploración, ya que el mal sabor de boca provocado por el tratamiento oral reducía las ganas de mamar y aumentaba su inquietud.
Lechones P: los lechones tratados con el protocolo P fueron directamente al pezón después del tratamiento, aumentando así el tiempo de lactación.
El tiempo de manejo en el grupo
O+P fue casi un 50 % superior al del grupo P.
Al estrés asociado a la manipulación, hay que sumar el relacionado con la administración de múltiples fármacos, que obviamente se reduce con un tratamiento combinado.
El cortisol es uno de los biomarcadores más utilizados para detectar estrés en cerdos. A este respecto, no hubo diferencias entre grupos en la concentración de cortisol basal un día antes de la administración del tratamiento y el día final del ensayo.
Por el contrario, se observó una tendencia estadística de menor concentración de cortisol en el día 0 para el Grupo P en comparación con el Grupo O+P, lo que sugiere un posible nivel más bajo de estrés.
En relación con el crecimiento, los lechones que solo recibieron tratamiento parenteral mostraron el mismo crecimiento que los lechones C que no recibieron ninguna manipulación.
Esto podría deberse al menor estrés que soportó el grupo P durante la administración del tratamiento en comparación con el grupo O+P.
El tratamiento oral no solo genera mal sabor, sino también una mayor sensación de saciedad, por lo que los lechones mamaron menos.
Los lechones que recibieron un tratamiento único mamaron más y tuvieron una ganancia diaria promedio mayor durante la lactancia, lo que se tradujo en un mayor peso al destete.

En conjunto, los hallazgos de este estudio refuerzan la importancia de considerar no solo la eficacia clínica de los tratamientos, sino también su impacto en el comportamiento y el bienestar de los lechones.
La combinación de hierro y anticoccidial en una única aplicación se perfila como una alternativa práctica y menos invasiva , capaz de mejorar tanto la salud como las condiciones de manejo en la explotación porcina.
Influencia del método de aplicación de productos de hierro y anticoccidios en el comportamiento de lechones lactantes y en los factores asociados a estrés
DESCÁRGALO EN PDF

Equipo Técnico Interporc
El sector porcino español está en un punto de inflexión. Tras una década de crecimiento, afronta nuevos retos con claridad de ideas, visión de largo plazo y una apuesta decidida por la sostenibilidad, la competitividad y la conexión con la sociedad. Esta fue la premisa del Foro Porcino Aragón organizado por INTERPORC y el Gobierno de Aragón en Zaragoza el pasado 8 de julio, donde se reunieron representantes institucionales, científicos, empresas, ganaderos y jóvenes profesionales para trazar las líneas estratégicas del futuro del porcino.
Objetivo: reforzar la posición del sector desde la evidencia técnica, la cohesión territorial y una narrativa compartida que refleje su papel esencial en el desarrollo económico y social del medio rural.
“
"El modelo está evolucionando y debemos anticiparnos con inteligencia y responsabilidad", afirmó Alberto Herranz, director general de INTERPORC. Su intervención marcó el tono de una jornada en la que se habló claro: el porcino no espera a que le marquen el camino, lo construye desde dentro, con datos, con compromiso y con una hoja de ruta compartida.

Sostenibilidad en su triple dimensión: ambiental, social y económica, con un enfoque técnico y realista.
Competitividad internacional: apostando por la digitalización, la formación y la eficiencia productiva.
Narrativa basada en hechos y ciencia: para combatir la desinformación y reforzar la confianza pública.
Lejos de discursos complacientes, el Foro sirvió para asumir los desafíos del presente con determinación y para impulsar una transformación que pone el foco en las personas que sostienen el sector: ganaderos, técnicos, empresas e instituciones comprometidas.
"El porcino genera más de 20.000 empleos directos y cuenta con más de 4.000 granjas en Aragón", recordó el presidente del Gobierno autonómico, Jorge Azcón. Pero las cifras son solo el punto de partida. A lo largo del Foro se evidenció que el valor del sector va más allá de lo económico: es un motor de vertebración rural, fijación de población y dinamización territorial.
En un contexto marcado por la despoblación y la transformación del medio rural, el porcino se consolida como pieza clave de un modelo productivo que convive con otras actividades como el turismo rural o la agroindustria, generando empleo estable, inversión e innovación en todo el territorio.
Uno de los mensajes más claros del Foro fue la necesidad de recuperar el relato del porcino desde el conocimiento y la credibilidad. Durante demasiado tiempo, el debate público ha estado condicionado por voces ajenas al sector y ha llegado el momento de reforzar el discurso desde dentro, con datos, transparencia y rigor técnico.
Varios participantes coincidieron en que el sector lleva años haciendo las cosas bien y comunicando con hechos, pero que necesitamos una narrativa común que llegue a la sociedad. En este sentido, se reivindicó el papel de los profesionales como portavoces legítimos de una actividad que alimenta, innova y cuida el entorno.
El Foro Porcino de Aragón no fue solo un encuentro sectorial. Fue un punto de partida para una nueva etapa, más cohesionada, más estratégica y con voluntad de alzar la voz con claridad y responsabilidad. La hoja de ruta está definida y el sector ha demostrado que tiene capacidad para liderar su transformación sin perder su esencia.

Foro Porcino Aragón: un paso al frente con visión, unidad y compromiso DESCÁRGALO EN PDF
Porque el porcino español no se conforma con resistir: quiere seguir siendo relevante en lo económico, en lo territorial y también en lo social. Y lo hace con visión, con argumentos y con un compromiso firme con el futuro del campo.
Laura Pérez Sala
Veterinaria especialista en producción porcina & Personal Coach

El verano suele ser una época especialmente complicada para el sector porcino. Aunque estamos acostumbrados a una alta rotación de personal y al abandono frecuente de puestos de trabajo, esta situación se acentúa durante los meses estivales.
La causa principal es el incremento de oportunidades laborales que surgen en otros sectores, especialmente el sector servicios, que experimenta un gran auge en verano debido al turismo
España se ha consolidado como un destino turístico de primer nivel, lo que se traduce en una avalancha de ofertas de empleo estacional: camareros, recepcionistas, personal de limpieza, guías turísticos, monitores, etc.
Hay dos aspectos clave que podríamos aprovechar:
Aunque resulta atractivo por la variedad de ofertas, no suele ofrecer grandes condiciones.
Los sueldos no son elevados.
Los horarios son largos y exigentes (fines de semana, noches, turnos partidos).
Muchas de las tareas no son motivadoras.
En cambio, el trabajo en una granja porcina, bien presentado, puede ser mucho más atractivo:
Implica contacto con animales.
Conlleva tareas variadas.
Presenta un entorno de trabajo con retos y aprendizaje constante.
El primer paso es generar interés en el sector, ya que muchos potenciales trabajadores tienen una imagen negativa o distorsionada del trabajo en una granja:
Piensan que es una actividad monótona, físicamente exigente y desarrollada en un entorno desagradable.
Para cambiar esta percepción, debemos comunicar con claridad los aspectos positivos del trabajo porcino.
Por ejemplo:
Frente a esta realidad, es importante que, en lugar de centrarnos en la queja, identifiquemos oportunidades y actuemos con estrategia.
El sector servicios no es ideal
Final de temporada: una oportunidad
A medida que el verano llega a su fin, también lo hacen muchos contratos temporales.
Octubre es uno de los meses con mayor incremento del paro.
En este contexto, el sector porcino tiene una gran oportunidad: Captar personal que queda disponible y ofrecerle un empleo estable, siempre que sepamos atraerlo y, sobre todo, retenerlo.
La tecnología aplicada a la producción. La importancia del trabajo en equipo.



El impacto directo que tiene sobre la alimentación y la economía local.


La posibilidad de aprender y progresar.
El contacto con animales.
A esto hay que sumarle una base imprescindible de condiciones dignas: Sueldo por encima del salario mínimo.





Horarios razonables.


Equipamiento de trabajo adecuado (ropa cómoda, abrigo en invierno, frescor en verano, calzado de seguridad).


Instalaciones adaptadas: duchas limpias con agua caliente, calefacción, lavadora para la ropa, sala de descanso limpia y confortable.



Diversos estudios coinciden en los factores que hacen que una persona se mantenga en su puesto de trabajo. Algunos de ellos son:
Es fundamental que el trabajador sepa qué se espera de él, reciba comunicación habitual (y respetuosa), y tenga espacios para el feedback constructivo.
La mayoría de personas no abandonan la empresa, sino a su responsable directo.
Buen ambiente laboral
El clima en el lugar de trabajo es un factor determinante.
Fomentar momentos agradables, espacios de relajación y una cultura de respeto genera cohesión
Gallup incluye entre sus indicadores de compromiso la pregunta: “¿Tienes algún amigo en el trabajo?”.

El sentido de pertenencia es clave: cuando alguien no se siente incluido, tenderá a marcharse o, en el peor de los casos, a boicotear el entorno.
Un plan de carrera claro, formación continua y capacitación adaptada son esenciales.
La sensación de avanzar, de adquirir maestría, de que uno mejora, es de las más gratificantes y motivadoras. Pero nadie nace sabiendo y hay que dar espacio al aprendizaje.
Las personas necesitamos entender el “por qué” de lo que hacemos. Esto incluye tanto las tareas más simples como el impacto global del trabajo.
En una granja, alimentamos al mundo, generamos empleo, dinamizamos el entorno rural. Participar en actividades locales, colaborar con iniciativas sociales o medioambientales del entorno da un sentido más profundo al trabajo y favorece el compromiso.



Es aquí donde hay que hacer un alto. No se trata solo de atraer talento, sino de adaptar el sector a las nuevas necesidades y formas de vida.
No es nada negativo ni juzgable que las personas quieran tener más calidad de vida, dedicar más tiempo a su familia o aficiones, y no sentirse esclavizadas por el trabajo.
¡Las nuevas generaciones tienen otras prioridades y el sector debe escucharlas! Resistirse al cambio es una pérdida de energía.
El futuro pasa por abrir la mente y explorar nuevas formas de trabajar:
Turnos rotativos que permitan la conciliación.
Horarios intensivos que liberen las tardes.
Flexibilidad real adaptada a cada contexto.
Mejora continua en la formación, digitalización y especialización de los equipos.
Tecnología: nos permite optimizar recursos, reducir tareas repetitivas y mejorar la calidad del entorno laboral. Sensores, robots de limpieza, sistemas automáticos de alimentación o climatización…Todo esto hace el trabajo más eficiente y, al mismo tiempo, más humano.

También se suele hablar mucho de la falta de compromiso de las nuevas generaciones.
Sin embargo, los datos no invitan a señalar con el dedo a nadie: según los últimos informes de Gallup, solo un 21% de los trabajadores están comprometidos con su empleo.

La motivación real está estrechamente relacionada con tres grandes necesidades psicológicas:

control sobre nuestras tareas, que se confía en nuestro criterio y se valora nuestra capacidad de decidir.
Percibir que mejoramos, que progresamos y que se nos reconocen los logros.
Si una granja porcina quiere atraer y retener talento, debe tener en cuenta estos elementos.
No se trata de grandes inversiones, no todo es culpa de las nuevas generaciones. Se trata de cambiar el enfoque: del control al respeto, del miedo a la confianza, de la queja a la propuesta.
Transformar el lugar de trabajo en un espacio donde las personas quieran quedarse es el reto más importante para asegurar la sostenibilidad de nuestro sector.
¡Ahora es el momento!
a un grupo, que somos parte de algo y que nuestra contribución tiene impacto.

Es momento de atraer y retener talento DESCÁRGALO EN PDF

Ibai, tu equipo es genial... Pero los porcinos son lo nuestro.



